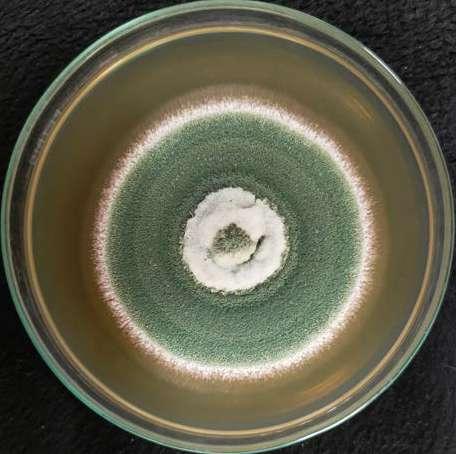
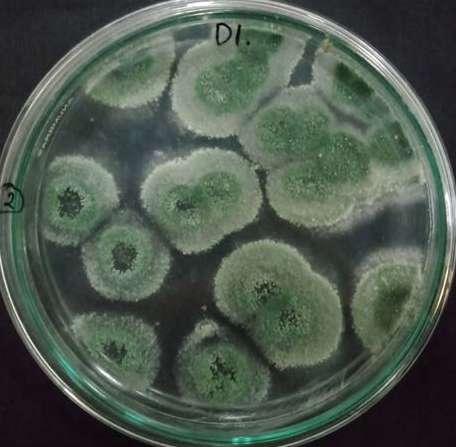

![]()







obecnie świat zmienia się szybciej niż kiedykolwiek wcześniej, a dynamika tych zmian może przytłaczać ludzi, którzy nie mają otwartych umysłów, nie śledzą nowinek i nie mają nawyku nieustannej nauki. Trudno wówczas mówić o efektywnym rozwoju biznesu. Dane statystyczne i prognozy na przyszłość pokazują, jak dynamiczny potencjał ma branża zoologiczna i jak szerokie pole dają wiodące trendy w opiece nad zwierzętami do skalowania, premiumizacji, personalizacji usług oraz innowacji. Według danych EUROMONITOR-a globalnie rynek opieki nad zwierzętami osiągnął w 2023 roku wartość około 197,6 mld USD i wzrost o 5,9 % rok do roku. W Polsce mamy sumę dogodnych warunków – rosnący rynek konsumencki, silny eksport, coraz bardziej wymagającego klienta, ale też coraz więcej konkurencji, a w związku z tym i potrzebę wyróżnienia się. „ZooBranża” nieustannie wspiera Państwa zarówno w pozyskiwaniu wartościowej i praktycznej wiedzy, jak i budowaniu umiejętności liderskich. Do skalowania biznesu i wzmacniania innowacyjności w branży zachęcają też największe targi zoologiczne, w których od dawna organizowane są strefy start-upów. Interzoo 2026 to przestrzeń, w której warto być – szczególnie jeśli mówimy o innowacji i młodych firmach. Oprócz Programu „Young Innovators” dedykowanego lokalnym start-upom, wspieranego przez niemieckie ministerstwo, odbędzie się już 3. edycja konkursu „Fresh Ideas Contest”, w którym jury nagrodzi najciekawsze innowacje, a do dyspozycji start-upów będzie scena prezentacyjna „Fresh Ideas Stage”. Nie ma rozwoju biznesu bez właściwego definiowania problemów i wyzwań, a także poznania potrzeb klientów. Zwłaszcza teraz, kiedy mamy tak konsumocentryczne podejście do doświadczeń zakupowych. Dla branży oznacza to potrzebę szybkiego reagowania, a nawet wyprzedzania trendów, dostosowywania komunikacji do różnych
grup wiekowych, korzystania z wielokanałowego dotarcia do klienta. Z danych Innova Market Insights wynika jasno: choć wszystkie pokolenia – Gen Z, Millenialsi, Gen X, Boomersi – dzielą pewne oczekiwania, jak zdrowie, dobre samopoczucie, przejrzystość, to jednocześnie każda grupa wybiera nieco inaczej. Starsi konsumenci preferują produkty tradycyjne, czyste, lokalne, młodsi zaś zwracają uwagę na trend, doświadczenie, emocje i szybkie zmiany. Na przykład w Europie aż 19% Gen Z deklaruje inwestycję w produkty podnoszące nastrój, podczas gdy Boomersi skupiają się na oszczędzaniu. W naszym kraju warto do tego pamiętać, że według raportu TGM StatBox aż ok. 70% polskich gospodarstw domowych ma zwierzaka, co stawia temat opieki nad zwierzęciem jako element codzienności. Klient dziś nie tylko chce najtańszej karmy, lecz rozwiązania pasującego do jego stylu życia, jego pupila i jego wartości.
Jeśli nałożymy na to wiodący trend humanizacji, to zakupy dla zwierząt są coraz częściej nie tylko potrzebą, lecz wyrazem emocji i stylu życia. A skoro zbliżamy się do najważniejszych i najbardziej rodzinnych świąt w ciągu roku, to oczywiste jest, że każde psiecko i kociecko wraz z opiekunami niecierpliwie czekają na prezenty… Ja już mam butelkę na wodę ze świątecznymi psiakami i hasłem „Merry Dogmas” – a jak Państwa firmy i sklepy przygotowały się do świątecznej kampanii? Możecie na nas liczyć, podsuwamy kilka interesujących pomysłów!
Zapraszam do lektury nowego wydania – będziemy wspólnie eksplorować, co w dzisiejszym świecie zoologii warto wiedzieć, przewidywać i wykorzystać. Bo choć pies i kot towarzyszą nam od lat, my dziś towarzyszymy im w nowy sposób – jako partnerzy, odbiorcy komunikacji i klienci, którzy oczekują więcej.
Joanna Zarzyńska Redaktor naczelna



03 Od redakcji
06 Echa Branży
10 IFEEDER – zrównoważenie w produkcji karm dla zwierząt domowych
16 Cele strategiczne i w miary w strategii. Jak działać świadomie i efektywnie?
22 Trade marketing w branży zoologicznej. Fundament skutecznej sprzedaży i rola MyPetStory Trade
28 Humanizacja zwierząt – nowe podejście do problemów otyłości
34 Psiecko i kociecko czekają na prezent świąteczny
50 Oś jelito – mózg. Jak mikrobiom jelitowy wpływa na zachowanie psa?
46 Pet Tech – technologia w opiece i treningu zwierząt
52 Wsparcie suplementacyjne dla kota w okresach nasilonego stresu
56 Grzyby entomopatogenne – innowacyjne narzędzie w walce z kleszczami
60 Zdrowy dziób i łapy papug
64 Kolorowe bogactwo Phu Quoc –jak wygląda handel rybami akwariowymi na wietnamskiej wyspie?
68 Co nowego na rynku?
74 Krzyżówka
Podziel się wiedzą! Zostań autorem „ZooBranży”. Skontaktuj się z nami. redakcja@zoobranza.com.pl








Małgorzata Biegańska-Hendryk
Techniczka weterynarii, behawiorystka zwierząt towarzyszących i zoodietetyczka kotów. Autorka książek i artykułów o kociej tematyce, twórczyni kierunku studiów podyplomowych „Behawiorystyka zwierząt towarzyszących – koty” na SWPS, prelegentka konferencji i szkoleń dotyczących kociego zachowania, zdrowia i żywienia. Od 2012 roku tworzy markę kocibehawioryzm.pl, prywatnie opiekunka czterech kotów: Stefana, Buni, Gaska i Imbira.
Adrianna Iwan
Mgr mikrobiologii, technik weterynarii, zoopsycholog, studentka medycyny weterynaryjnej na Uniwersytecie Przyrodniczym w Lublinie, współpracuje z Fundacją Badamy Suplementy.
Katarzyna Lipska
Konsultantka biznesowa z doświadczeniem w projektowaniu wizualnych systemów zarządzania oraz wspieraniu rozwoju kompetencji pracowników, a także analiz strategicznych. Posiada doświadczenie łączące różne perspektywy: od środowiska start-upowego po duże organizacje – w każdym kontekście potrafi dostosować metodykę do sytuacji klienta. Absolwentka Politechniki Warszawskiej i Akademii Leona Koźmińskiego. Pasjonatka gotowania i pływania.
Natalia Młodnicka
Behawiorystka, trenerka i zoopsycholożka psów, dietetyczka psów i kotów. Absolwentka Polskiej Akademii Zoopsychologii i Animaloterapii w Krakowie. Od lat związana z branżą zoologiczną. Prowadzi bloga Na każdą łapę, gdzie dzieli się wiedzą z zakresu wychowania oraz opieki nad psami. Prywatnie opiekunka dwóch psów.
Lara Moody
Jest dyrektorem wykonawczym Institute for Feed Education. Zapewnia wizjonerskie przywództwo w działaniach publicznej organizacji charytatywnej, w tym rozwój programów, partnerstwa strategiczne i wspólne pozyskiwanie zasobów. Współpracuje z AFIA w celu kontynuowania i komunikowania pracy instytutu, tworzy możliwości zaangażowania darczyńców i kontynuowania dialogu na temat ważnych kwestii mających wpływ na przemysł paszowy.
Ada Włoch
Biolog, zoopsycholog, technik weterynarii. Od 2017 roku pracuje z papugami. Członek World Parrot Trust, a także IAABC. Prowadzi kanał na Youtube, bloga na FB oraz IG. Udziela konsultacji prywatnym opiekunom i placówkom zajmującym się papugami. Wielokrotny gość programów telewizyjnych, gazet czy radia. Prywatnie opiekunka sześciu adopciaków: Żako Karola, afrykanek kongijskich Buby, Kajko i Kokosza, a także piony niebieskogłowej Aryi i piony brązowoskrzydłej Fiony.
mgr inż. Paweł Wróblewski
Katedra Genetyki i Ochrony Zwierząt, Instytut Nauk o Zwierzętach, Szkoła Główna Gospodarstwa Wiejskiego w Warszawie. Od najmłodszych lat związany z akwarystyką. Pasjonat i hodowca pielęgnic z jeziora Tanganika.
dr n. wet. Joanna Zarzyńska
Od 2006 r. pracuje naukowo na stanowisku adiunkta w Katedrze Higieny Żywności i Ochrony Zdrowia Publicznego IMW SGGW w Warszawie. Interesuje się tematyką nowej żywności, badaniami konsumenckimi, zagadnieniami One Health i wpływem produkcji żywności na klimat. Pasjonatka kynologii, jeździectwa oraz teatru.

z BIOFEED!
Rok 2025 przyniósł kolejną edycję Pucharu Polski w Dogtrekkingu, a BIOFEED wraz z marką EUPHORIA po raz kolejny dołączyli do grona sponsorów wspierających cały cykl. Rosnąca popularność dogtrekkingu przyciągnęła zarówno doświadczonych zawodników, jak i wielu debiutantów. W sezonie odbyło się sześć wydarzeń w malowniczych lokalizacjach: Lublińcu, Bielsku-Białej, Parku Śląskim, Ustrzykach Dolnych, Wiśle i Złotym Stoku. Każdy etap wyróżniał się wyjątkową atmosferą, sportową rywalizacją i energią płynącą ze współpracy człowieka i psa. BIOFEED i EUPHORIA towarzyszyli uczestnikom przez cały sezon, przygotowując pakiety startowe oraz nagrody w postaci karmy Euphoria Fresh. To zaangażowanie zostało ponownie docenione, co tylko potwierdza, że promowanie aktywności i zdrowego stylu życia w duecie opiekun – pies jest dla firmy czymś więcej niż obowiązkiem – to jej misja i prawdziwa pasja!


Finał Pucharu Polski w Dogtrekkingu 2025







FEDIAF EuropeanPetFood, głos europejskiego przemysłu karmy dla zwierząt domowych, ogłosił powołanie Milicy Jevtić na nową Sekretarz Generalną ze skutkiem od 3 listopada 2025 r. Milica wnosi prawie 20 lat doświadczenia w zakresie spraw publicznych UE, rzecznictwa oraz zarządzania organizacjami branżowymi. W czasie swojej kariery Milica kierowała zespołami i inicjatywami, które przynosiły znaczące rezultaty w zakresie działań politycznych oraz sprzyjały konstruktywnemu dialogowi między przemysłem a instytucjami. Współpracownicy cenią ją za uczciwość, opanowane przywództwo oraz umiejętność przekładania złożonych zagadnień na jasne strategie.
Jako Sekretarz Generalna Milica będzie współpracować z członkami i partnerami FEDIAF, aby wzmocnić rolę Stowarzyszenia jako zaufanego głosu europejskiego przemysłu karmy dla zwierząt domowych, promując bezpieczną, pożywną i zrównoważoną karmę oraz podkreślając pozytywną rolę zwierząt domowych w społeczeństwie. – POLKARMA z zadowoleniem przyjmuje informację o powołaniu Milicy Jevtić na stanowisko Sekretarz Generalnej FEDIAF – powiedział Maciej Przeździak, Sekretarz Generalny POLKARMA Polskie Stowarzyszenie Producentów Karm dla Zwierząt Domowych. – Liczymy, że dzięki jej bogatemu doświadczeniu w organizacjach branżowych koordynowanie istotnych tematów i reprezentowanie branży na poziomie UE oraz Państw Członkowskich będzie jeszcze skuteczniejsze. Ponadto Franco Garbelotto, obecnie Manager ds. Spraw Publicznych i Komunikacji, obejmie funkcję Zastępcy Sekretarza Generalnego od 1 stycznia 2026 r., wspierając strategiczne i operacyjne zarządzanie Stowarzyszeniem wraz z Sekretarz Generalną.
Procedura POLKARMA
Natua Luxury tuńczyk z homarem dostała wyróżnienie w konkursie Pet Choice Award. Wyróżnienie zostało przyznane przez niezależne grono ekspertów programu Pet Choice Award i potwierdza wysoką jakość, prawidłowy skład i akceptację konsumencką.
Pet Choice Award to konkurs dla producentów karm dla psów i kotów.
dotycząca działań w sytuacji nieprzestrzegania zasad poprawnego znakowania karmy dla psów i kotów
Celem inicjatywy jest wyróżnienie marek, które tworzą receptury oparte na wiedzy naukowej, odpowiadające fizjologicznym potrzebom zwierząt towarzyszących, a jednocześnie stawiają na bezpieczeństwo, transparentność i najwyższą jakość składników.

Oceny dokonuje niezależna Komisja złożona z ekspertów rynku paszowego, lekarzy i dietetyków weterynaryjnych, techników, behawiorystów i trenerów, biorąc pod uwagę: skład surowcowy i analityczny, wygląd, sensorykę, funkcjonalność i innowacyjność oraz transparentność etykiety.
Wyłącznym dystrybutorem włoskiej marki Natua w Polsce jest AniDis. Zapraszamy do kontaktu: anidis.pl, kontakt@anidis.pl

11 października 2025 r. we Wrocławiu odbyła się Konferencja Żywieniowa Brit zorganizowana przez markę Brit Veterinary Diets. Wydarzenie miało miejsce we wrocławskim hotelu The Bridge MGallery i zgromadziło lekarzy weterynarii, techników oraz studentów, oferując im aktualną wiedzę z zakresu dietetyki weterynaryjnej. Program konferencji obejmował wykłady ekspertów, takich jak dr med. vet. Stefanie Handl, dr med. vet. Irene Bruckner, DVM Inês Carvalho, dr Jacek Wilczak oraz DVM PhD Paweł Kucharski. Tematyka spotkania koncentrowała się na praktycznych aspektach żywienia psów i kotów, w tym zarządzaniu dietą w zaburzeniach żołądkowo-jelitowych, przewlekłej chorobie nerek, alergiach pokarmowych, otyłości, żywieniu seniorów oraz wsparciu dietetycznym w problemach kardiologicznych. Konferencja stanowiła platformę wymiany wiedzy i doświadczeń, wspierając rozwój praktyki klinicznej w zakresie żywienia zwierząt. Z niecierpliwością czekamy na organizację kolejnego wydarzenia w przyszłym roku. karmybrit.pl
Wsparcie dla start-upów: ekskluzywne pakiety targowe i wsparcie dla młodych firm na targach Interzoo 2026
Interzoo 2026
Targi Interzoo 2026 wspierają start-upy i innowatorów z branży artykułów dla zwierząt domowych, oferując specjalne powierzchnie wystawiennicze i formaty, takie jak Fresh Ideas Stage. Oprócz międzynarodowej strefy dla start-upów zagranicznych program Young Innovators, dotowany przez niemieckie Federalne Ministerstwo Gospodarki i Energii (BMWE), oferuje kompleksowe wsparcie finansowe, aby pomóc młodym firmom z Niemiec wziąć udział w wiodących światowych targach branży zoologicznej. Targi Interzoo, które odbędą się w Norymberdze w dniach 12–15 maja 2026 r. , są najważniejszym na świecie miejscem spotkań międzynarodowej branży artykułów dla zwierząt domowych oraz forum wymiany kreatywnych pomysłów i promocji produktów i usług. Oprócz prezentacji wybitnych marek te wiodące na świecie targi skupiają uwagę na nowych uczestnikach rynku jako innowacyjnych motorach rozwoju branży. Nowatorskie pomysły i innowacje na scenie Fresh Ideas Stage Targi Interzoo 2026 zapewniają ogromną widoczność nowatorskim pomysłom biznesowym i innowacjom odzwierciedlającym najnowsze trendy na scenie Fresh Ideas Stage w hali 3 . To właśnie tutaj nowo powstałe firmy mogą zaprezentować swoje pomysły na start-upy, innowacyjne produkty i usługi oraz najnowsze tematy branżowe w krótkich prezentacjach. W piątek podczas imprezy odbędzie się trzecia edycja popularnego konkursu Fresh Ideas Contest , w którym uczestnicy prezentują swoje innowacje publiczności i jury złożonemu z ekspertów, aby zdobyć jedną z prestiżowych nagród. Fresh Ideas Stage stanowi nie tylko platformę dla nowych pomysłów biznesowych, lecz także okazję dla innowatorów i założycieli firm do osobistego poznania się w strefie wypoczynkowej obok sceny i omówienia aktualnych trendów w branży artykułów dla zwierząt domowych. Więcej informacji na temat udziału można znaleźć na stronie: https://interzoo-fresh-ideas.com
Specjalny pakiet usług dla międzynarodowych start-upów

Aby wesprzeć nowicjuszy z siedzibą poza granicami Niemiec, targi Interzoo 2026 oferują również atrakcyjny pakiet usług dostosowany do potrzeb międzynarodowych start-upów w ramach Międzynarodowej Strefy Start-upów. Korzyści płynące z pakietu obejmują powierzchnię wystawienniczą w pawilonie oraz wybór usług marketingowych, które umożliwiają również mniejszym firmom poszerzenie zasięgu komunikacyjnego i zwiększenie sukcesu targowego. Więcej informacji można znaleźć na stronie: https://www.interzoo.com/en/exhibit/participate-as-startup/international-start-up-area W środę, 3 grudnia 2025 r. o godz. 10.00 odbędzie się webinar dla wystawców na Interzoo 2026, wspomagający skuteczne działania targowe.
Link do zapisów: https://meety.clickmeeting.com/257781825/register
Betta zaprasza do współpracy
Betta sp. z o.o. jest importerem i dystrybutorem Marek: Almo Nature, FidoVet, Gosbi, M-Pets, MenForSan, Naturo, Oasy i Plutos. Wszystkie produkty, które znajdziesz w naszej ofercie, wyróżniają się bardzo wysoką jakością. Jesteśmy przekonani, że zdrowie każdego zwierzaka zaczyna się w jego misce, dlatego oferujemy karmy i przysmaki tworzone z najlepszych składników, zgodnie z najwyższymi standardami jakości, a akcesoria i kosmetyki stanowią doskonałe uzupełnienie naszej oferty. Serdecznie zapraszamy do współpracy sklepy działające w branży zoologicznej.
Dział Obsługi Klienta: tel. 22 763 19 90; e-mail: biuro@betta.pl; platforma B2B: www.betta.pl

KOMUNIKAT PRASOWY EUROMONITOR: zmiany na rynku opieki nad zwierzętami
Główne wnioski z raportu:
• Zmiana preferencji konsumentów na rzecz kotów przekształca wydatki na karmę dla zwierząt.
• Karma dla kotów napędza wzrost wolumenu, karma dla psów dominuje wartościowo.
• Myślenie „prewencja, zamiast leczenia” kształtuje przyszły rozwój rynku opieki nad zwierzętami.
„Petflacja” oraz zmiany demograficzne wśród populacji zwierząt domowych przekształcają globalny rynek opieki nad zwierzętami, którego wartość w 2025 r. wynosi 207 mld USD. Jak wynika z danych firmy analitycznej Euromonitor International, karma dla kotów staje się kluczowym czynnikiem wzrostu. Zgodnie z raportem Euromonitor International „World Market for Pet Care 2025”, karma dla kotów była najszybciej rosnącą kategorią, osiągając CAGR na poziomie 6%, podczas gdy karma dla psów zwiększyła się jedynie o CAGR 3,8% w latach 2020–2025. Ta zmiana wskazuje, że opiekunowie zwierząt coraz częściej wybierają koty ze względu na niższe koszty utrzymania i ich mniejsze wymagania. Do 2030 r. prognozuje się, że wartość rynku karmy dla kotów będzie rosła w tempie CAGR 4%.
Odwołując się do najnowszych danych i trendów rynkowych z platformy wiedzy Euromonitor International Passport, Sahiba Puri, globalna menedżerka ds. analiz rynku opieki nad zwierzętami, powiedziała: – Niepewność gospodarcza staje się coraz większym wyzwaniem dla branży. Mimo wcześniejszej odporności rynku, cierpliwość konsumentów się wyczerpuje, gdy dalszy wzrost cen coraz mocniej obciąża ich budżety.
Preferowanie kotów napędza zmiany demograficzne w populacji zwierząt domowych; małe psy zyskują większą sympatię
Preferowanie kotów jako domowych pupili rośnie zarówno w tradycyjnie zorientowanych na psy regionach,

takich jak Ameryka Północna i Europa Zachodnia, jak i na rynkach wschodzących, w tym w regionie Azji i Pacyfiku. Do tej zmiany przyczyniają się m.in. rosnące koszty posiadania psa, zwłaszcza dużych ras. Surowe regulacje dotyczące posiadania psów oraz czynniki kulturowe w regionie Azji i Pacyfiku dodatkowo wzmacniają popularność kotów. Mimo to psy nadal dominują pod względem wolumenu sprzedaży karmy – szacuje się, że do 2030 r. będą odpowiadać za 66% globalnej sprzedaży karmy dla zwierząt. W Ameryce Północnej udział dużych psów spadnie z 32% populacji psów w 2020 r. do 27% w 2030 r. Jednocześnie udział małych psów wzrośnie z 42% do 46%.
Wolumeny karmy dla kotów rosną, psy napędzają wartość rynku Mimo że w kilku kluczowych krajach liczba kotów przekracza liczbę psów, to psy nadal będą odpowiadały za znaczącą część wydatków na karmę. W Ameryce Północnej karma dla psów będzie stanowić 68% łącznej wartości sprzedaży karmy dla psów i kotów do 2030 r., utrzymując dominację rynku psów. W Europie Zachodniej karma dla psów pozostanie odpowiedzialna za 45% tej kategorii. Trendy te podkreślają znaczenie odpowiednio dostosowanych strategii – od premiumizacji karmy dla psów w celu maksymalizacji przychodów po koncentrację na droższych produktach w kategorii karmy dla kotów, aby dostać się na falę prognozowanego wzrostu (ryc. 1.).
Nowy model zarządzania zdrowiem zwierząt Opiekunowie zwierząt coraz częściej przyjmują proaktywne podejście do zdrowia swoich pupili, co napędza popyt na produkty oferujące konkretne korzyści. Suplementy diety dla zwierząt odnotowały najszybszy wzrost w ostatnich pięciu latach. Producenci dostrzegają jednak, że możliwości wykraczają poza suplementy – obejmując karmę i przysmaki dla zwierząt. Skupienie na wyspecjalizowanych potrzebach, spersonalizowanej opiece i formułach opartych na nauce może istotnie wzmocnić wizerunek marki i wyróżnić ją na rynku.
Wielkość i wzrost regionalnego rynku pet care w kategoriach, prognoza na lata 2025–2030
Ameryka Północna Europa Zachodnia Azja-Pacyfik Ameryka Łacińska Europa Wschodnia Australazja Bliski Wschód i Afryka

Wielkość rynku w mln USD
Źródło: Euromonitor International

Więź między końmi a psami zawsze była silna – w stajniach, na zawodach, a nawet w domu. W odpowiedzi na rosnącą popularność tego połączenia spoga horse 2026, wiodące międzynarodowe targi branży jeździeckiej, wprowadza zupełnie nową atrakcję: DOG VILLAGE powered by pet. Po raz pierwszy dostawcy produktów dla psów otrzymają w Kolonii dedykowaną, prestiżową przestrzeń wystawienniczą w dniach 7–9 lutego 2026 roku.
Ponad połowa właścicieli koni mieszka również z psem. Fakt ten znacząco wpływa na rozwój produktów oraz zachowania zakupowe na rynku jeździeckim. Nowe DOG VILLAGE powered by pet odzwierciedla ten styl życia, oferując markom z segmentów karm, akcesoriów, pielęgnacji, zdrowia i produktów lifestyle’owych dla psów skoncentrowaną i inspirującą przestrzeń prezentacyjną w samym sercu najważniejszego europejskiego miejsca spotkań branży jeździeckiej.
– Dzięki nowemu DOG VILLAGE powered by pet chcemy wypełnić lukę rynkową. W poprzednich edycjach spoga horse mieliśmy już wielu wystawców oferujących zarówno produkty dla koni, jak i dla psów. Czekali oni na możliwość obsłużenia obu grup docelowych na jednych targach. Dlatego jestem niezwykle szczęśliwy, że możemy w tym roku zaprezentować ten ekscytujący format – mówi Bernd Voss, dyrektor spoga horse 2026. Przy niemal całej powierzchni wystawienniczej już zarezerwowanej i zaledwie kilkoma małymi dostępnymi jeszcze przestrzeniami spoga horse 2026 zapowiada kontynuację swojej historii sukcesu jako kluczowe miejsce spotkań międzynarodowego biznesu jeździeckiego.

© Koelnmesse GmbH, Oliver Wachenfeld
Czy reprezentujesz firmę działającą w sektorze produktów dla psów?
Jeśli tak, DOG VILLAGE powered by pet oferuje Ci idealną okazję, aby zaprezentować swoje produkty wykwalifikowanej publiczności branżowej, nawiązać kontakty z czołowymi podmiotami rynku oraz odkryć ekscytujące synergie między światem psów i koni.
Dołącz do DOG VILLAGE podczas spoga horse 2026: tam, gdzie innowacja spotyka się ze stylem życia, a dwa światy łączą się pod jednym dachem.
Zarezerwuj stoisko już teraz: www.spogahorse.com


Wywiad z: Larą Moody
Dyrektor wykonawczą IFEEDER
Joanna Zarzyńska, ZooBranża: Jakie trendy w zakresie zrównoważonego rozwoju dominują obecnie w branży karm dla zwierząt?
Lara Moody, IFEEDER: Istnieje wiele trendów dotyczących zrównoważonego rozwoju w kontekście karm dla zwierząt – od materiałów opakowaniowych i sposobu pozyskiwania składników po odporność łańcucha dostaw. Biorąc pod uwagę zakres działań Instytutu Edukacji i Badań nad Paszami (IFEEDER), skupmy się na składnikach. Jednym z głównych trendów, który wciąż dominuje w branży karm dla zwierząt, jest wykorzystanie składników pochodzących z recyklingu/ upcyklingu – czyli pozyskiwanie produktów ubocznych z innych gałęzi przemysłu i ponowne ich wykorzystanie w sposób, który zapobiega trafianiu ich na wysypiska, a jednocześnie utrzymuje je w obiegu gospodarczym. Według raportu IFEEDER „2025 Pet Food Report” 50% składników karm dla zwierząt pochodzi z recyklingu z innych sektorów przemysłu. Spośród pięciu głównych kategorii składników karm dwie to: produkty z kurczaka oraz produkty wołowe – obie obejmują surowce pochodzące z renderingu, co pozwala branży bezpiecznie i efektywnie odzyskiwać wysokiej jakości składniki oraz ograniczać wykorzystanie surowców pier-
wotnych. W praktyce oznacza to mniej odpadów, mniejsze obciążenie gruntów i zasobów wodnych oraz ograniczenie emisji gazów cieplarnianych. Producenci karm podejmują także działania w swoich zakładach. W 2024 roku IFEEDER opublikował zestaw studiów przypadków, prezentujących przykłady działań członków branży w ramach ich własnych inicjatyw zrównoważonego rozwoju – od redukcji i odzysku wody po działania wspierające schroniska dla zwierząt.
JZ: Jakie wskaźniki należy priorytetowo monitorować, aby wiarygodnie oceniać zrównoważony rozwój karm dla zwierząt (np. emisję CO2 , zużycie wody, powierzchni, transport, upcykling)?
LM: Ustalanie priorytetów w zakresie zrównoważonego rozwoju to decyzja indywidualna. Przy opracowywaniu programu zrównoważonego rozwoju liderzy firm muszą określić, gdzie i w jaki sposób ich organizacja może wywierać największy wpływ – zwykle zaczynając od oceny istotności (ang. materiality assessment). „Istotność” to próg, od którego dane zagadnienie staje się na tyle ważne, że firma powinna o nim raportować. Na przykład bezpieczeństwo w miejscu pracy jest istotne dla długoterminowego dobrostanu pracowników oraz zaufania inwestorów i społeczności. Uznanie bezpieczeństwa pracy za temat istotny w ramach programu zrówno -
ważonego rozwoju oznacza, że firma nadaje mu wagę, ustala punkt odniesienia dla ciągłego doskonalenia i mierzy postępy w realizacji celów. W ujęciu szerszym kwestie istotne obejmują największy wpływ organizacji na gospodarkę, środowisko i społeczeństwo. IFEEDER opracował poradnik pod tytułem „Defining Material Issues”, pomagający określić, które kwestie mogą być istotne dla firm z branży pasz i dlaczego. W kontekście środowiskowym zaleca on analizę takich aspektów, jak zużycie energii, emisja gazów cieplarnianych, wykorzystanie zasobów lądowych i morskich, gospodarka odpadami, jakość i zużycie wody.
JZ: Jak wyniki analiz cyklu życia (LCA) diet roślinnych wypadają w porównaniu z dietami mięsnymi w kontekście karm dla psów i kotów oraz jakie są największe ograniczenia tych analiz?
LM: Porównanie wyników analiz LCA (ang. Life Cycle Assessment) diet roślinnych i mięsnych w kontekście karm dla psów i kotów jest bardzo zróżnicowane, ponieważ zależy od tego, czy receptura opiera się na składnikach pierwotnych, czy też na produktach ubocznych pochodzących z innych branż. Baza danych Global Feed LCA Institute (GFLI) gromadzi rosnący zbiór informacji o śladzie środowiskowym składników i może służyć do oceny wpływu środowiskowego danej receptury. Każdy przepis można przeanalizować, jednak wynik zależy od wielu czynników i niuansów.
JZ: Na ile realne i skalowalne jest szersze wykorzystanie składników z upcyklingu i renderingu w karmach dla zwierząt oraz jakie bariery technologiczne, sanitarne i rynkowe należy pokonać?
LM: Słowo „rendering” często budzi negatywne skojarzenia, jednak w rzeczywistości rendering to proces transformacji, który pozwala odzyskać wartościowe
białka, tłuszcze i minerały z części zwierząt, które nie są spożywane przez ludzi, ale są całkowicie bezpieczne i strawne dla zwierząt domowych. Składniki pochodzące z renderingu są wytwarzane w inspekcjonowanych zakładach, poddawane obróbce cieplnej w celu eliminacji patogenów i testowane pod kątem rygorystycznych norm jakościowych – co oznacza, że mają bardzo wysoką jakość i bezpieczeństwo. W przypadku karm dla zwierząt kluczowe pytanie brzmi nie czy składnik nadaje się do spożycia przez człowieka, lecz czy zapewnia odpowiednią wartość odżywczą i spójność jakościową.
JZ: Jak firmy powinny równoważyć wybór składników „premium” (np. ryb morskich) z ich śladem środowiskowym, biorąc pod uwagę rosnący popyt na tego typu produkty?
LM: Wybór składników to złożony proces. Decyzja o wykorzystaniu surowców pierwotnych, produktów ubocznych lub współproduktów jest zależna od indywidualnych celów i priorytetów każdej firmy.
JZ: W jaki sposób przejrzystość łańcucha dostaw (np. identyfikowalność składników) wpływa na wiarygodność deklaracji dotyczących zrównoważonego rozwoju i jak można ją poprawić?
LM: Przejrzystość łańcucha dostaw ma kluczowe znaczenie dla wiarygodności deklaracji dotyczących zrównoważonego rozwoju. Duża część badań IFEEDER wspiera tworzenie przejrzystości między branżą, naukowcami a konsumentami. W sektorze pasz dla zwierząt opracowano zharmonizowaną metodologię i bazę danych do oceny wpływu środowiskowego składników paszowych – dostępną w ramach bazy GFLI. Jest ona coraz częściej wykorzystywana przez uczestników łańcucha dostaw, co stanowi krok w kierunku bardziej świadomych i zrównoważonych decyzji.

JZ: Jaką rolę mogą odgrywać certyfikaty i standardy (np. zrównoważone rybołówstwo, certyfikaty upcyklingu) w komunikowaniu wartości środowiskowych karm dla zwierząt konsumentom?
LM: Certyfikaty i standardy odgrywają istotną rolę w komunikowaniu wartości środowiskowych produktów. Zrównoważony rozwój w kontekście karm obejmuje wiele aspektów: pozyskiwanie surowców, przetwarzanie, pakowanie, ślad węglowy, dobrostan zwierząt i gospodarkę odpadami. Certyfikaty upraszczają te złożone kwestie do rozpoznawalnych oznaczeń lub etykiet, które ułatwiają konsumentom zrozumienie, że dany produkt wspiera odpowiedzialne praktyki środowiskowe. Certyfikaty uznanych organizacji – np. MSC (zrównoważone rybołówstwo), Upcycled Certified™, Organic czy B Corp – dają konsumentom pewność, że deklaracje dotyczące zrównoważonego rozwoju są niezależnie weryfikowane, a nie są jedynie elementem marketingu. Tworzą one wspólny język zrównoważonego rozwoju, ułatwiając porównywanie produktów według spójnych kryteriów.
JZ: Jakie są skutki ekonomiczne rosnącego popytu na karmy dla zwierząt dla rolników i społeczności wiejskich oraz jak można zapewnić sprawiedliwy podział korzyści?
LM: Wpływ gospodarczy przemysłu karm został przeanalizowany w raporcie IFEEDER Pet Food Report 2025.
W Stanach Zjednoczonych w ciągu roku wyprodukowano 9,8 mln ton karm dla psów i kotów, co przełożyło się na 13,2 miliarda dolarów przychodów ze sprzedaży produktów rolnych. IFEEDER koncentruje się na badaniach i danych, jednak sprawiedliwy podział korzyści to kwestia, która wymaga działań na poziomie polityki federalnej i stanowej.
JZ: Jak sektor karm dla zwierząt może współpracować z innymi branżami (spożywczą, rolniczą, odpadową) oraz instytucjami badawczymi, by przyspieszyć dekarbonizację i wdrożenie gospodarki o obiegu zamkniętym?
LM: Najlepszym sposobem na przyspieszenie działań w zakresie zrównoważonego rozwoju i wykorzystania składników pochodzących z recyklingu jest podejmowanie decyzji opartych na rzetelnych danych. Rozbudowa bazy danych GFLI o kolejne składniki oraz jej aktywne wykorzystanie dostarczają informacji całej branży.
JZ: Jakie luki badawcze pozostają w naszej wiedzy o wpływie środowiskowym karm dla zwierząt (np. brak danych regionalnych, problemy metodologiczne w analizach LCA, długoterminowe skutki dla zwierząt i konsumentów) i które z nich IFEEDER lub inne organizacje powinny priorytetowo badać?
LM: Istnieje wiele luk badawczych dotyczących wpływu środowiskowego karm dla zwierząt, co wynika z ogromnej złożoności tego tematu – obejmującej m.in. różnice regionalne w produkcji, szczegóły dotyczące transportu i brak badań długoterminowych.
IFEEDER współpracuje z uczestnikami łańcucha dostaw w celu dodania lub aktualizacji danych dotyczących upraw rolnych w bazie GFLI, tak aby lepiej odzwierciedlała ona realia produkcji rolnej w USA. Wciąż istnieje wiele składników wymagających uzupełnienia, a podobne prace powinny być prowadzone również przez przedstawicieli innych regionów. W publikacjach dotyczących zrównoważonego rozwoju IFEEDER zawsze jasno określa, co zostało, a czego nie można było uwzględnić w badaniach, zachęcając inne organizacje do uzupełniania tych braków. JZ: Dziękuję za rozmowę.

Na platformie YT można odsłuchać wywiad z Larą Moody przeprowadzony przez prof. Jana Suchodolskiego na kanale The Pet Food Science Podcast (skanując kod QR). What’s Behind Ingredient Trends? – Lara Moody









Jak działać świadomie i efektywnie?


Po misji i wizji przychodzi czas na kolejny fundament strategii – cele strategiczne. Po dzisiejszym tekście chciałabym, żebyście Państwo zdobyli umiejętność definiowania celów strategicznych i operacyjnych, wiedzieli, jak dobrać miary, a także jak cele i miary pomagają mierzyć strategię oraz operacjonalizować ją w codziennym zarządzaniu firmą.
Cele pozwalają mierzyć sukces. Bez jasnych celów i sposobu ich weryfikacji nie da się ocenić, czy podejmowane działania przynoszą oczekiwane efekty.
Dlaczego cele są tak ważne?
Ponieważ nadają kierunek działań – jasno pokazują, co dla firmy jest priorytetem, na czym warto się skoncentrować i co wzmacniać. Motywują do działania – każda codzienna decyzja i wysiłek pracowników nabierają sensu, a tym bardziej, kiedy są powiązane z celem strategicznym, który ma wpływ na całość. Pozwalają także mierzyć sukces. Bez jasnych celów i sposobu ich weryfikacji nie da się ocenić, czy podejmowane działania przynoszą oczekiwane efekty.
Według słownika języka polskiego „cel” to zamierzony rezultat działania, to, do czego ktoś dąży lub co pragnie osiągnąć. A jak w takim razie zdefiniować pojęcie „cel strategiczny”? To długoterminowy, kluczowy dla rozwoju firmy zamierzony rezultat, który określa, co organizacja chce osiągnąć w perspektywie kilku lat, aby realizować swoją misję i wizję.
Cel stanowi również motywację wewnętrzną: jest zarówno zamiarem osiągnięcia określonego stanu, jak i przewidywanym skutkiem działań. To właśnie te dwa elementy – zamiar i skutek – są rdzeniem każdego celu w strategii. Dzięki nim firma nie tylko wie, co chce osiągnąć, lecz także może świadomie planować kolejne kroki i monitorować efekty swoich działań.
Cele strategiczne zamieniają kierunek na działanie, porządkują priorytety i pozwalają prowadzić biznes świadomie – niezależnie od tego, czy prowadzicie sklep zoologiczny, sieć gabinetów weterynaryjnych, czy jesteście producentem karm i akcesoriów. Ale same cele strategiczne nie wystarczą. Bez dobranych mierników, które mówią, czy idziemy we właściwą stronę, strategia pozostaje zbiorem pięknych zdań. Dlatego właśnie bez miar cały system celów się sypie. To jak ustawić kierunek
marszu, ale nie mieć sposobu, by sprawdzić, czy idziemy w dobrą stronę i z właściwą prędkością.
Po co w ogóle cele strategiczne?
Cele strategiczne to nie tylko liczby czy „punkt na mapie”. To przyszłościowy obraz działań firmy, który wynika zarówno z jej własnych potrzeb, jak i wymagań otoczenia rynkowego. Innymi słowy, cel strategiczny pokazuje co chcemy osiągnąć i dlaczego warto w to inwestować. Wspomniane cele strategiczne są odzwierciedleniem wartości firmy, jej aspiracji, analiz wewnętrznych i zewnętrznych oraz oceny ryzyka, a także rozmów z Klientami. Dlaczego są tak ważne? Bo wyznaczają kluczowe kierunki, na których firma musi się skoncentrować, aby skutecznie realizować swój cel nadrzędny. To one nadają tempa, porządkują priorytety i pozwalają zespołom działać w sposób spójny i świadomy.
Ale czy tylko powinniśmy bazować na celach strategicznych?
Gdy już wiemy, co chcemy osiągnąć, kolejnym krokiem jest uporządkowanie celów według rodzaju i czasu realizacji. W tej części przyjrzymy się celom strategicznym i operacyjnym, pokazując, czym się różnią i jak każdy z nich wspiera realizację strategii firmy. Jest kwestią istotną, żeby potrafić to rozróżnić. Nie każdy cel jest taki sam – niektóre wyznaczają kierunek na kilka lat, inne dotyczą najbliższych miesięcy, tygodni czy dni. W firmie zoologicznej cel strategiczny może dotyczyć np. zwiększenia udziału w rynku karm weterynaryjnych, podczas gdy cel operacyjny – liczby zamówień zrealizowanych w ciągu dnia w sklepie online.
Aby skutecznie zarządzać firmą, warto rozróżniać powyższe rodzaje celów (strategiczne i operacyjne), a do
każdego dopasować odpowiednie miary sukcesu. Dzięki temu każda decyzja, zarówno w gabinecie weterynaryjnym, jak i w dziale sprzedaży, jest spójna z ogólną filozofią firmy, a realizacja krótkoterminowych zadań faktycznie przybliża do osiągnięcia długoterminowych ambicji.
Zacznijmy od celów strategicznych, czyli tego, co chcemy osiągnąć w perspektywie kilku lat. Cele strategiczne wyznaczają główne kierunki rozwoju firmy i są ambitne – wymagają wyjścia poza dotychczasowe doświadczenia, ale pozostają możliwe do osiągnięcia, o czym szczegółowo trochę później.
Cele strategiczne powinny odzwierciedlać ambicję, ale nie ograniczać kreatywności zespołu. Muszą wynikać z misji firmy, tak aby były drogowskazem. A do tego powinniśmy dobrać wskaźniki sukcesu w postaci KPI (key performance indicator) lub OKR (objecitive key result), które pozwolą monitorować postęp w czasie. Przykłady celów strategicznych w firmach zoologicznych:
• Osiągnąć 20% udziału w rynku karm weterynaryjnych dla psów i kotów w ciągu trzech lat.
• Otwarcie pięciu nowych gabinetów weterynaryjnych oferujących kompleksową opiekę profilaktyczną w ciągu dwóch lat.
• Wprowadzić na rynek nową linię suplementów dla zwierząt generującą 15% przychodów firmy w ciągu 12 miesięcy od premiery.
• Sprawić, aby 30% wszystkich zamówień było realizowanych przez kanały online w ciągu 18 miesięcy.
• Zdobyć certyfikaty i rekomendacje od 80% współpracujących gabinetów weterynaryjnych w ciągu dwóch lat, prowadząc równocześnie kampanię edukacyjną dla właścicieli zwierząt.
Cele operacyjne, czyli co chcemy osiągnąć dziś, w tym tygodniu, w tym miesiącu?
Cele operacyjne to codzienne lub tygodniowe działania, przybliżające do realizacji celów strategicznych. Są konkretne, mierzalne i łatwe do kontroli.
Przykłady celów operacyjnych w firmach zoologicznych:
• dzienne: czas realizacji zamówienia online <48 godzin, liczba nowych klientów zapisanych do newslettera = 50.
• tygodniowe: liczba konsultacji weterynaryjnych przeprowadzonych w gabinecie, liczba nowych leadów pozyskanych w sklepach stacjonarnych.
Dlaczego są tak istotne? Pozwalają szybko reagować na bieżące wyzwania i podejmować konkretne działania oraz ułatwiają monitorowanie efektywności działań w krótkim horyzoncie. A także są kaskadą celów strategicznych do poszczególnych obszarów organizacji. Dlatego właśnie cele operacyjne są nie tyle dodatkiem, co warunkiem powodzenia celów strategicznych.
Obiecałam, że omówimy, kiedy cel jest ambitny, bo to jest naprawdę ciekawe zagadnienie, które budzi wiele pytań. Chcę zwrócić Państwa uwagę na to, że nie każdy cel przewyższający dotychczasowe wyniki jest ambitny. Cel staje się naprawdę ambitny, gdy wymaga od zespołu wyjścia poza pewne schematy, mobilizuje do kreatywnego działania i wymaga podniesienia standardów pracy.
Przykład:
• Firma zoologiczna, która rocznie rośnie o 5%, wyznacza cel wzrostu o 8%. Formalnie jest to poprawa, ale nie jest ambitnym celem – nie wymaga znaczącego wysiłku ani innowacji.

• Natomiast wzrost sprzedaży o 20% w tym samym czasie, przy wprowadzeniu nowej linii produktów i rozwoju kanałów online, to cel ambitny, bo wymaga planowania, współpracy zespołu i wyjścia poza dotychczasowe doświadczenia.
Warto przy tym pamiętać, że ambitny cel nie oznacza celu nierealnego. Powinien być formą wyzwania, ale możliwego do osiągnięcia przy rozsądnym wykorzystaniu zasobów i planowaniu.
Uważaj, by cel nie ograniczał – czyli teoria H. Simona
Herbert A. Simon, twórca koncepcji ograniczonej racjonalności, przypominał, że menedżerowie podejmują decyzje w warunkach niepełnej informacji, ograniczonego czasu i ograniczonych zdolności poznawczych. W praktyce oznacza to, że rzadko wybieramy optymalne rozwiązanie. Najczęściej wybieramy to, które jest wystarczająco dobre – czyli zadowalające.
To ważne, bo pokazuje, że cele również tworzymy w warunkach ograniczeń. Nie są one obiektywnym obrazem najlepszej możliwej przyszłości firmy, lecz efektem naszych przekonań, emocji, dotychczasowych doświadczeń i tego, co w danym momencie uważamy za realne.
I właśnie dlatego cele – zamiast pomagać – czasami mogą organizację ograniczać. Zgodnie z teorią Simona, źle sformułowane cele mogą zamykać organizację w schematach, ograniczać elastyczność strategiczną, zmniejszać zdolność dostrzegania alternatyw, prowadzić do podejmowania decyzji „w granicach celu”, a nie w granicach rzeczywistych możliwości firmy lub rynku. I tu powstaje pytanie – to w takim razie kiedy cel zaczyna być ograniczeniem, a przestaje być naszym drogowskazem?
• Gdy jest zbyt wąski (np. „zwiększyć sprzedaż jednej kategorii karm”). Taki cel blokuje otwarcie się na nowe trendy, np. diety naturalne, suplementy funkcjonalne, żywienie specjalistyczne.
• Gdy prowadzi firmę tylko jedną ścieżką – jeśli skupimy się wyłącznie na rozwoju sklepów stacjonarnych, możemy przega -
pić potencjał e-commerce albo usług dodatkowych (np. dietety ki zwierzęcej, teleporad wetery naryjnych).
• Gdy powstaje na bazie prze konań, a nie aktualnej wiedzy – działając w warunkach ogra niczonej racjonalności, możemy tworzyć cele oparte na przesta rzałych założeniach. W efekcie cel zaczyna zawężać myślenie, zamiast otwierać nowe kierun ki.
• Gdy promuje decyzje pozornie dobre, ale szkodliwe – cel typu „obniżyć koszty o 10%” może skończyć się spadkiem jakości obsługi lub produktów – a więc uderzyć w to, co w branży zoolo gicznej jest kluczowe: zaufanie klientów.
• Gdy przestaje być aktualny, ale nadal jest realizowany – cel, który staje się rytuałem, pro wadzi firmę w przeszłość, a nie w przyszłość.
Żeby cel wspierał rozwój firmy, a nie ją zamykał, powinien być wy starczająco szeroki, by nie zamy kać drogi do nowych możliwości, regularnie weryfikowany, np. co kwartał, elastyczny wobec zmian rynkowych, powiązany z leading indicators, które wcześniej sygnali zują, że kierunek przestaje działać, oparty na wartościach i misji, a nie tylko na danych liczbowych.
Miary – jak sprawdzić, że cel jest realizowany?
Miary są kluczowym elemen tem każdego celu, bo to one po zwalają sprawdzić, czy firma rze czywiście posuwa się naprzód. Cel bez miary pozostaje jedynie dekla racją – dopiero liczby zmieniają go w narzędzie zarządzania. W prak tyce oznacza to, że nie wystarczy postawić sobie za zadanie „popra wić obsługę klienta” czy „zwiększyć sprzedaż w sklepie online”. Trzeba jasno określić, po czym poznamy, że naprawdę to robimy. Dlatego w każdej firmie tak ważne są KPI, KBI czy OKR i różne typy wskaźni ków, które pomagają nie tylko oce niać wyniki, lecz także przewidy wać, czy te wyniki w ogóle nadejdą. KPI (key performance indica tors), czyli kluczowe wskaźniki efek tywności, są najczęściej stosowaną miarą. Dobre KPI są zawsze powią zane z celem, logiczne, mierzalne,


mają jasno określonego właściciela i przede wszystkim wymuszają decyzje. W branży zoologicznej KPI mogą dotyczyć jakości obsługi (np. NPS klientów), logistyki (czas realizacji zamówień), efektywności sprzedaży (średnia wartość koszyka). Z kolei niewłaściwie dobrane KPI to często takie, które niczego nie zmieniają i nie prowadzą do żadnej decyzji/ akcji, jak liczenie liczby postów w mediach społecznościowych czy liczby wysłanych maili, które nie mają przełożenia na zachowania klientów ani na wynik.
Obok KPI warto stosować także KBI (key behavior indicators) – wskaźniki zachowań, które pokazują nie to, co osiągnęliśmy, ale to, co robimy, aby osiągnąć pożądany wynik. To szczególnie ważne, bo wiele firm mierzy jedynie efekt, po czym orientuje się, że jest już za późno na reakcję. Tymczasem to właśnie KBI – mierzące konkretne działania pracowników – pozwalają sterować wynikiem, zanim się wydarzy. W firmach zoologicznych mogą to być takie zachowania, jak liczba przeprowadzonych konsultacji żywieniowych czy częstotliwość kontaktu z klientem w przypadku problemów z zamówieniem. KPI mówią o efekcie (np. średni koszyk 120 zł), a KBI o zachowaniu, które do tego prowadzi (np. prezentowanie zestawów pakietowych każdemu klientowi). Bez KBI firma reaguje dopiero na spadki. Z KBI – działa wyprzedzająco.
Miary i cele można łączyć również w systemie OKR , który składa się z jednego celu jakościowego (objective) oraz zestawu mierzalnych rezultatów (key results). To podejście świetnie sprawdza się wszędzie tam, gdzie priorytety muszą być ambitne, ale jednocześnie przejrzyste. Na przykład celem może być zwiększenie zaangażowania klientów w sklepie online, a mierzalnymi rezultatami –pozyskanie 20% nowych klientów, zwiększenie średniej wartości koszyka o 15% oraz pozyskanie pięciu nowych recenzji sklepu tygodniowo w trzecim kwartale. W takim
ujęciu KPI i KBI stają się dodatkowymi wskaźnikami, które wspierają realizację Key Results – KPI pokazują efekt, KBI monitorują codzienne zachowania i działania prowadzące do wyniku.
Jednym z najważniejszych elementów systemu miar są wartości docelowe, czyli targety. Każda miara, aby była użyteczna, musi odpowiadać na pytanie: ile znaczy „dobrze”? Bez tego nie wiadomo, czy osiągnięty poziom jest sukcesem, czy jedynie przypadkowym wynikiem. Targety mogą dotyczyć obsługi (NPS powyżej 65), logistyki (czas realizacji zamówienia poniżej 48 godzin), stabilności bazy klientów (poniżej 4%) lub efektywności sprzedaży (średni koszyk powyżej 120 zł). Target pozwala podejmować decyzje: utrzymać kierunek, skorygować działania lub zainicjować interwencję, jeśli wynik odbiega od oczekiwań. Aby lepiej rozumieć naturę miar, warto rozróżniać wskaźniki lagging i leading . Lagging indicators – takie jak przychód, zysk czy liczba reklamacji – mówią nam o przeszłości. Są ważne, ale zawsze spóźnione. Pokazują, jaki był efekt, ale nie powiedzą, że za miesiąc ten efekt przestanie być satysfakcjonujący. Dlatego warto korzystać także z leading indicators, czyli wskaźników wyprzedzających. To miary, które sygnalizują przyszłe wyniki, zanim te faktycznie się pojawią. W branży zoologicznej mogą nimi być: liczba nowych leadów, aktywność klientów w sklepie online, frekwencja w gabinetach groomerskich, liczba zapytań o konkretną kategorię produktów czy liczba koszyków porzuconych przed finalizacją transakcji. Leading indicators pozwalają przewidywać trendy i reagować, zanim KPI zaczną spadać.
Pułapka mierzenia tego, co łatwe
Ostrzegam! W wielu firmach panuje pokusa, by mierzyć to, co najprościej policzyć – liczbę postów, newslet-
terów czy produktów w ofercie. Problem w tym, że te łatwe wskaźniki zwykle nie mówią nic o rzeczywistym postępie. Tworzą jedynie iluzję kontroli: liczby rosną, ale firma może stać w miejscu, bo żaden z tych wskaźników nie pokazuje, czy cele są realizowane, ani nie wymusza żadnych decyzji.
Dobra miara bywa czasami znacznie trudniejsza do zdefiniowania, ale jest użyteczna – realnie pokazuje, czy posuwamy się naprzód. Dlatego zamiast mierzyć aktywność, warto mierzyć efekt: nie liczbę postów, lecz zaangażowanie użytkowników, nie liczbę konsultacji, lecz ich jakość, nie liczbę nowych produktów, lecz ich rotację i wpływ na sprzedaż.
Podsumowując…
W dobrze zbudowanym systemie miar wszystkie elementy wzajemnie się uzupełniają: KPI pokazują, czy cel jest realizowany, KBI – czy zespół zachowuje się w sposób prowadzący do wyniku, OKR nadają kierunek i określają ambitne rezultaty, targety wyznaczają standard, „jak powinno być”, a wskaźniki leading i lagging pomagają odpowiednio wcześnie reagować i potwierdzają faktyczne efekty. Razem tworzą system, który nie tylko mierzy strategię, lecz przede wszystkim pozwala ją wdrażać, korygować i codziennie przekładać na realne decyzje. W firmach zoologicznych cele dotyczą wielu obszarów – od sprzedaży i marketingu, przez jakość obsługi zwie -
rząt i ich opiekunów, po współpracę zespołową, rozwój gabinetów weterynaryjnych, edukację oraz budowanie silnego wizerunku. Niezależnie od obszaru, zasada jest jedna: cele określają, co chcemy osiągnąć, a miary mówią, czy naprawdę to robimy.
System celów i miar działa jak układ nerwowy organizacji. Ambitne cele popychają firmę do rozwoju, ale to miary utrzymują ją na właściwej ścieżce. Bez nich nawet najlepiej brzmiąca strategia traci znaczenie – to jak znać kierunek, ale nie sprawdzać, czy faktycznie się w nim poruszamy. Dobrze sformułowane, regularnie mierzone i konsekwentnie realizowane cele pozwalają przewidywać rozwój, monitorować efektywność działań, budować zaangażowanie pracowników i dostarczać realną wartość zarówno klientom, jak i ich zwierzętom. Strategia przestaje wtedy być teorią, a staje się praktycznym narzędziem prowadzącym firmę do trwałych, mierzalnych i widocznych sukcesów. Dobra strategia to nie dokument – to codzienna praktyka. A praktyką staje się dopiero wtedy, gdy cele są jasne, mierzalne i konsekwentnie analizowane.
A gdybyście Państwo chcieli jeszcze bardziej zgłębić tę tematykę – zachęcam do kontaktu katarzyna.lipska@4results.pl lub przeczytania case study o tym, jak pomagamy firmom, na naszej stronie internetowej www.4results.pl


Fundament skutecznej sprzedaży i rola MyPetStory Trade
Współczesny handel detaliczny przestał być jedynie miejscem wymiany towaru na pieniądze. W czasach rosnącej konkurencji, rosnącej liczby marek oraz coraz bardziej świadomych konsumentów, sama promocja produktowa skierowana do odbiorcy końcowego przestaje wystarczać. Tu z pomocą przychodzi trade marketing – obszar działań marketingowych skupionych na partnerach biznesowych, takich jak dystrybutorzy, sieci handlowe i sklepy detaliczne. W przeciwieństwie do klasycznego marketingu konsumenckiego, który ma przyciągać uwagę klienta końcowego, trade marketing koncentruje się na wsparciu sprzedaży w kanale dystrybucji. Celem jest nie tylko zwiększenie dostępności produktów, ale przede wszystkim zwiększenie ich widoczności, atrakcyjności i rotacji w punkcie sprzedaży, a także budowanie długotrwałych relacji z partnerami handlowymi.
Podstawowe założenia
Trade marketing to szeroki wachlarz działań obejmujących:
1. Promocje i oferty handlowe – rabaty, bonusy, pakiety startowe dla sklepów, dzięki którym produkty szybciej trafiają na półki.
2. Materiały POS (Point of Sale) – standy, ekspozytory, wobblery i plakaty, które wyróżniają produkty w sklepie i przyciągają uwagę klienta.
3. Programy motywacyjne – konkursy i systemy premiowe dla doradców i pracowników sklepów, zwiększające zaangażowanie w sprzedaż marki.
4. Szkolenia i edukacja personelu – działania podnoszące wiedzę sprzedawców o produktach, dzięki czemu rekomendacje są bardziej wiarygodne i skuteczne.
5. Analiza i raportowanie działań – pomiar wyników kampanii, rotacji produktów i efektywności działań w poszczególnych punktach sprzedaży.
W praktyce trade marketing łączy strategię marketingową marki z praktycznymi potrzebami dystrybutorów i detalistów, umożliwiając skuteczniejszą realizację celów sprzedażowych.
Znaczenie trade marketingu w branży zoologicznej
Branża zoologiczna jest specyficzna: klienci są świadomi potrzeb swoich pupili, a wybory zakupowe często zależą od wiedzy i rekomendacji personelu sklepu. Właśnie dlatego trade marketing odgrywa tu kluczową rolę.
Dzięki odpowiednim akcjom B2B, producenci mogą:
• edukować sprzedawców o właściwościach karm, suplementów i akcesoriów,
• zwiększać widoczność marek w małych i średnich sklepach,
• motywować partnerów do promowania nowych produktów i bestsellerów,
• efektywnie zarządzać kampaniami promocyjnymi w całej sieci sprzedaży.
Efektywne wykorzystanie trade marketingu pozwala nie tylko zwiększyć sprzedaż, ale również budować lojalność sklepów i klientów, którzy widzą markę nie tylko w reklamach, ale również w sklepie i w rekomendacjach sprzedawcy.
• Łatwiejszy dostęp do najnowszych ofert
• Lepsza ekspozycja produktów
• Większa wiedza doradców
• Zwiększenie sprzedaży i powracalności klientów
• Nagrody za zaangażowanie w postaci voucherów
• Oszczędność czasu i łatwa obsługa akcji
• Lepsze relacje z producentami i dostawcami
Tradycyjny trade marketing, choć skuteczny, wiązał się z wieloma wyzwaniami: koniecznością ręcznego monitorowania akcji w setkach punktów sprzedaży, trudnościami w rozliczaniu nagród czy ograniczoną możliwością raportowania efektywności.
Platforma MyPetStory Trade wprowadza w branży zoologicznej digitalową transformację trade marketingu. Integruje klasyczne działania marketingowe z technologią, umożliwiając producentom i dystrybutorom:
• tworzenie akcji marketingowych online i przypisywanie ich do wybranych sklepów,
• monitorowanie postępów i statusów realizacji zadań w czasie rzeczywistym,
• rozliczanie nagród i premii w sposób automatyczny i przejrzysty,
• edukowanie sprzedawców i motywowanie ich do aktywnego promowania produktów.
MyPetStory Trade pozwala zamienić tradycyjne, papierowe procesy w inteligentne i mierzalne działania B2B, co przekłada się na zwiększoną efektywność, oszczędność czasu oraz większą kontrolę nad budżetem i wynikami kampanii.

Funkcje MyPetStory Trade – jak działa nowoczesny trade marketing
1. Tworzenie i zarządzanie akcjami marketingowymi
Marki mogą samodzielnie planować kampanie, określać budżet, wybrać sklepy, ustalać ramy czasowe i definiować szczegółowe zadania dla punktów sprzedaży. Mogą to być zadania typu „zrób i udokumentuj” (np. zdjęcie ekspozycji) lub „użyj kuponu”, a także dołączać instrukcje i materiały graficzne.
2. Przydzielanie zadań sklepom Sklepy otrzymują jasne instrukcje: co kupić, jak wyeksponować produkty, jak dokumentować zadania. Panel producenta pozwala przypisać zadania konkretnym placówkom lub zaprosić nowe punkty do udziału w akcji.
3. Monitorowanie i raportowanie Platforma umożliwia śledzenie statusu każdej akcji i zadania: od przydzielenia, przez przesłanie do oceny,
Zakupy 1
Szkolenie
Wsparcie sprzedaży
Instrukcja ekspozycji

Zaliczenie szkolenia Zdjęcie Ekspozycji


Sklep przystępuje do akcji 2 3 4
aż po zatwierdzenie lub odrzucenie. Producent widzi też zużycie budżetu, postęp kampanii i liczbę uczestniczących sklepów.
4. System nagradzania
Sklepy zgłaszają realizację zadań, które są weryfikowane przez producenta. Nagrody przyznawane są indywidualnie i wypłacane cyfrowo (np. e vouchery). W przypadku niepoprawnej realizacji zadania, sklep może zostać poproszony o poprawę.
5. Komunikacja B2B i oferty handlowe Platforma umożliwia wysyłanie ofert handlowych do sklepów, salonów groomerskich i dystrybutorów, a także generowanie kuponów B2B, które sklepy mogą przekazywać klientom.
6. Transparentność i kontrola kosztów
Organizator akcji ma pełną kontrolę nad budżetem i wydatkami. System pozwala na przejrzyste rozliczanie kampanii i weryfikację kosztów w czasie rzeczywistym.
7. Panel biznesowy i zespołowa praca
Zdjęcie Faktury
Rejestracja Sell-outów

Akceptacja zadań i nagrody dla sklepu
Dostęp do intuicyjnego panelu pozwala zarządzać markami, akcjami i budżetami. Możliwa jest delegacja zadań w zespole i tworzenie raportów analitycznych do podejmowania decyzji opartych na danych.
8. Wsparcie dla małych i średnich sklepów
Platforma jest przyjazna także dla mniejszych sklepów, które mogą łatwo przyłączyć się do akcji producentów, wykonywać zada -
Odbiór nagrody przez pracownika sklepu

Tradycyjny trade marketing, choć skuteczny, wiązał się z wieloma wyzwaniami: koniecznością ręcznego monitorowania akcji w setkach punktów sprzedaży, trudnościami w rozliczaniu nagród czy ograniczoną możliwością raportowania efektywności. Platforma MyPetStory Trade wprowadza w branży zoologicznej digitalową transformację trade marketingu.
nia i odbierać nagrody bez skomplikowanych procedur.
Podsumowanie
Trade marketing w branży zoologicznej jest niezbędnym narzędziem do budowania przewagi konkurencyjnej. Dzięki MyPetStory Trade klasyczne działania marketingowe stają się cyfrowe, mierzalne i bardziej efektywne. Platforma umożliwia lepszą współpracę, producentom i dystrybutorom, hurtowniom i sklepom. W czasach, gdy decyzje zakupowe klientów coraz częściej zależą od wiedzy i rekomendacji doradcy w sklepie, MyPetStory Trade staje się kluczowym narzędziem w strategii B2B, które pozwala markom zwiększać sprzedaż, a sklepom efektywnie realizować swoje cele biznesowe. Trade marketing w branży zoologicznej to dziś nie tylko dodatek do strategii sprzedaży – to kluczowy

element budowania przewagi konkurencyjnej. Skuteczna współpraca producentów ze specjalistycznymi sklepami zoologicznymi jest absolutnie niezbędna.
Platforma MyPetStory Trade pokazuje, jak tradycyjne działania trade marketingowe można przekształcić w cyfrowe, mierzalne i w pełni kontrolowane kampanie B2B, które realnie zwiększają sprzedaż, poprawiają wiedzę sprzedawców i umacniają relacje między markami a sklepami. Warto pamiętać, że skuteczny trade marketing to strategia, systematyczność i mierzalność. Platformy takie jak MyPetStory Trade dają markom i sklepom narzędzia do planowania, realizacji i monitorowania akcji w jednym miejscu, minimalizując ryzyko błędów i maksymalizując efektywność.
Dla producentów branży zoologicznej oznacza to możliwość
świadomego zarządzania kanałami sprzedaży, zwiększania udziału w półce oraz tworzenia długotrwałej lojalności wśród sklepów partnerskich. Dla sklepów – jasny plan działania, realne korzyści z zaangażowania i wsparcie w edukacji klienta. W rezultacie trade marketing w wydaniu MyPetStory Trade nie jest już jedynie narzędziem wspierającym sprzedaż – staje się strategicznym motorem wzrostu, który łączy efektywność biznesową z wartością dodaną dla partnerów i klientów. W czasach dynamicznego rozwoju rynku zoologicznego, skuteczne wykorzystanie takich narzędzi może przesądzać o sukcesie zarówno producentów, jak i specjalistycznych sklepów. Jeśli prowadzisz sklep zoologiczny już dziś zaloguj się w Panelu MyPetStory na panel.mypetstory.pl i przystąp do Akcji Trade Marketingowych.
Pluxee w jednej z 40 sieci handlowych na terenie całej Polski:


Jak dobra karma wspiera zdrowie psów jesienią i zimą?
Jesień i zima to okres, w którym odporność naszych czworonogów jest szczególnie narażona na osłabienie. Zmienna pogoda, krótsze dni i mniejsza aktywność sprzyjają spadkowi formy, a tym samym zwiększają podatność na infekcje. Wielu opiekunów właśnie wtedy zaczyna szukać skutecznych sposobów na wzmocnienie organizmu pupila. Warto pamiętać, że odporność w dużej mierze zaczyna się… w misce. Odpowiednio dobrana karma może realnie wspierać układ odpornościowy psa, poprawiać jego kondycję oraz chronić przed sezonowymi spadkami formy.
Składniki wspierające odporność
Dieta psa powinna dostarczać nie tylko energii, lecz także składników, które aktywnie wzmacniają układ odpornościowy. Do najważniejszych należą:
• Kwasy tłuszczowe omega-3 i omega-6 (zawarte w oleju z łososia) – wspierają zdrowie skóry i sierści, które stanowią pierwszą barierę ochronną przed drobnoustrojami. Działają przeciwzapalnie i poprawiają kondycję skóry.
• Chelaty aminokwasowe mikroelementów (cynku, żelaza, selenu, manganu i miedzi) – to wyjątkowo dobrze przyswajalne formy minerałów, które wspierają odporność, kondycję oraz zdrową skórę i sierść. Powstają przez połączenie minerałów z aminokwasami, dzięki czemu organizm „widzi” je bardziej jak białko niż zwykły minerał – i dzięki temu przyswaja go skuteczniej.
• Prebiotyki FOS i MOS – stymulują rozwój korzystnych bakterii jelitowych, które wzmacniają naturalne mechanizmy obronne organizmu.
• Probiotyki (Lactobacillus paracasei, drożdże) – pomagają utrzymać równowagę mikroflory jelitowej, co bezpośrednio przekłada się na lepsze trawienie i silniejszy układ immunologiczny.
• Naturalne dodatki roślinne (jabłka, bataty, siemię lniane, jagody rokitnika, karczoch, ostropest i natka pietruszki) – to bogate źródła błonnika, karotenoidów
i antyoksydantów. Wspierają trawienie, oczyszczanie organizmu oraz ogólną odporność.
Wszystkie te kluczowe składniki znajdziesz w karmach Euphoria Fresh, które zostały opracowane tak, aby kompleksowo wspierać odporność psa właśnie wtedy, gdy organizm potrzebuje tego najbardziej.
Świeży indyk lub wieprzowina – sekret zdrowia i energii
Każda receptura Euphoria Fresh zawiera aż 30% świeżego indyka lub wieprzowiny oraz do 56% mięsa i składników pochodzenia zwierzęcego. Dzięki temu karma jest wyjątkowo smakowita i bogata w pełnowartościowe białko, tłuszcze oraz energię. Taki skład przekłada się na lepsze samopoczucie i silniejszy układ odpornościowy –szczególnie w okresie jesienno-zimowym, gdy organizm potrzebuje dodatkowego wsparcia.
Euphoria Fresh – odporność przez cały rok
Euphoria Fresh to linia karm, które wspierają odporność nie tylko sezonowo, lecz przez cały rok. Pokarm bogaty w świeżego indyka lub wieprzowinę, olej z łososia, chelaty aminokwasowe i naturalne dodatki roślinne wzmacnia organizm od środka, poprawia kondycję skóry i wspiera prawidłową pracę jelit – a to właśnie tam zaczyna się odporność. Dlatego warto rekomendować karmy, które nie tylko smakują, lecz realnie wspierają układ immunologiczny psa – każdego dnia, o każdej porze roku.


RECEPTURA BEZ PSZENICY I KURCZAKA
Bez dodatku kurczaka i pszenicy, ryż jako jedyne zboże.

WYSOKA ZAWARTOŚĆ BIAŁKA
Aż do 56% mięsa i składników pochodzenia zwierzęcego.
Linia karm super premium, która w naturalny sposób wzmacnia odporność psów wszystkich ras – od szczeniąt po dorosłe zwierzęta.
5 wariantów ze świeżym indykiem lub wieprzowiną dla dorosłych psów.
2 warianty ze świeżym indykiem dla szczeniąt.
Wszystkie karmy dostępne w 2 wersjach: dla ras małych oraz średnich i dużych
Dostępne również receptury monoproteinowe
ŚWIEŻOŚĆ W SKŁADZIE
Aż 30% świeżego indyka lub wieprzowiny.
CHELATY AMINOKWASOWE
Lepsza przyswajalność mikroelementów (cynk, żelazo, selen, mangan, miedź).

Nowe podejście do problemów otyłości u psów i kotów

Tekst: Joanna Zarzyńska
Współczesny świat opieki nad zwierzętami domowymi coraz bardziej przypomina relacje międzyludzkie. „Humanizacja” – czyli przenoszenie emocji, stylu życia i potrzeb człowieka na czworonogiego towarzysza – stała się dominującym trendem w branży pet care. Opiekunowie traktują swoich pupili jak członków rodziny: zapraszają je do stołu, gotują, nagradzają przysmakami, a często reagują na ich uczucia jak na ludzkie. Niestety, te dobrze pojęte uczucia często mają niezamierzone konsekwencje zdrowotne – jedną z najpoważniejszych jest otyłość. U ludzi jest ona zaliczana do chorób cywilizacyjnych, coraz częściej to samo mówi się o zwierzętach, o epidemii otyłości zwłaszcza tych zwierząt, których opiekunami są mieszkańcy krajów rozwiniętych.
Zwierzęta domowe odgrywają w życiu współczesnych ludzi rolę terapeutów emocjonalnych, zastępców brakujących relacji społecznych, a czasami nawet substytutów dla dzieci, zwłaszcza wśród młodszych pokoleń. W takim kontekście karmienie zwierzęcia staje się aktem miłości i międzygatunkowego porozumienia.
Otyłość u psów i kotów stanowi jedno z najpoważniejszych wyzwań współczesnej medycyny weterynaryjnej. Według raportu Association for Pet Obesity Prevention (APOP) z 2022 r. aż 59% psów i 61% kotów w USA zostało sklasyfikowanych jako mające nadwagę lub otyłość. Według nowych badań opublikowanych w „Journal of Veterinary Internal Medicine” (2024) nawet 60% psów i 55% kotów w Europie ma nadwagę lub otyłość. A inna grupa naukowców po przeanalizowaniu wyników z wizyt w klinikach weterynaryjnych w USA oszacowała, że częstość stanów nadwagi i otyłości wzrosła w ciągu ostatnich 20. Lat. To nie tylko problem estetyczny – otyłość skraca życie zwierząt średnio o dwa lata, zwiększa ryzyko cukrzycy, chorób stawów, serca oraz nowotworów. Otyłe koty mają pięciokrotnie wyższe ryzyko zachorowania na cukrzycę niż koty o prawidłowej masie ciała. Według badań statystycznych około 40% psów i kotów w Polsce ma problem z nadmierną masą ciała. Liczby te wskazują na to, że otyłość zwierząt domowych nie jest już marginalnym problemem klinicznym, lecz epidemią zdrowotną wymagającą natychmiastowej interwencji na wielu poziomach: edukacyjnym, weterynaryjnym i społecznym. Problem jest szczególnie widoczny w przypadku kotów. Koty domowe niewychodzące są bardziej zagrożone otyłością, jeśli są wysterylizowane lub wykastrowane (co zmniejsza zapotrzebowanie kaloryczne o 30%), są w średnim wieku (8–12 lat) lub spędzają całe życie w warunkach domowych bez możliwości realizowania naturalnej aktywności. Komfort życia otyłych
kotów jest drastycznie niski. Często żyją one w przewlekłym bólu (ból stawów), poczuciu braku bezpieczeństwa i niemożliwości realizacji swoich naturalnych zachowań. Z kolei wśród ras psów najwyższy wskaźnik otyłości odnotowano u labradorów (63%), beagli (59%) i owczarków niemieckich (47%).
Problem komplikuje fakt, że wiele osób nie potrafi prawidłowo ocenić masy ciała swojego zwierzęcia. Mimo, wydawałoby się, prostych kryteriów diagnostycznych, jak choćby skala BCS – większość opiekunów nie dostrzega, że ich zwierzę ma problemy z utrzymaniem prawidłowej masy ciała, łatwo tłumacząc dodatkowe kilogramy jako „zdrowy zapas” czy „krągłości”, a pulchnego pupila jako słodkiego.
Humanizacja zwierząt domowych –psychologiczne podłoże trendu karmienia
Humanizacja zwierząt, zwana również antropomorfizmem, to zjawisko polegające na przypisywaniu zwierzętom ludzkich cech, emocji i potrzeb psychicznych. W kontekście żywienia zwierząt domowych humanizacja przejawia się poprzez traktowanie jedzenia nie tylko jako środka do zaspokojenia podstawowych potrzeb biologicznych, lecz jako formy wyrażenia miłości, afektu i emocjonalnej więzi. Ten trend znacząco nasilił się w ciągu ostatnich 15 lat wraz z rosnącą świadomością społeczną i tzw. pet parentingiem – opiekunami, którzy identyfikują się bardziej jako rodzice niż właściciele zwierząt. Psychologiczne podłoże tego zjawiska jest głębokie i zrozumiałe. Zwierzęta domowe odgrywają w życiu współczesnych ludzi rolę terapeutów emocjonalnych, za -

Regularny ruch, dostosowany do wieku i kondycji psa, pomaga nie tylko utrzymać prawidłową masę ciała, lecz także wspiera pracę stawów, układu krążenia i ogólną sprawność organizmu. Jednak nie w każdym przypadku jesteśmy w stanie zapewnić psu wysoką aktywność, dlatego kluczowa jest dobrze dobrana, zbilansowana dieta dostosowana do poziomu aktywności i potrzeb energetycznych psa.

Karma sucha diaeta Peter I z królikiem firmy 77 Seven Seven to niskokaloryczna, hipoalergiczna receptura (339 kcal/100 g) zawiera 48% królika i indyka oraz 0% dodatku zbóż i cukrów. Dzięki lekkostrawnym białkom, ograniczonym tłuszczom i wysokiej zawartości błonnika stanowi doskonałe rozwiązanie dla psów mało aktywnych i z tendencją do nadwagi. Karma została przygotowana w niskiej temperaturze 77 °C, co pozwala zachować wartość odżywczą i naturalny smak, bez sztucznych konserwantów i wzmacniaczy.
To propozycja zgodna z ideą „zdrowego minimalizmu” w żywieniu – wysoka jakość, prosty skład, zero zbędnych dodatków. https://www.77seven-seven.pl/product-page/peter-i-z-królikiem
stępców brakujących relacji społecznych, a czasami nawet substytutów dla dzieci, zwłaszcza wśród młodszych pokoleń. W takim kontekście karmienie zwierzęcia staje się aktem miłości i międzygatunkowego porozumienia. Dla wielu ludzi, którzy borykają się z samotnością, depresją lub brakiem silnych relacji społecznych, interakcja z zwierzęciem podczas karmienia stanowi jeden z niewielu momentów bezwarunkowej akceptacji i więzi. Ta dynamika psychiczna czyni nadzwyczaj trudnym zadaniem przekazanie opiekunowi informacji, że karmienie zwierzęcia w sposób tradycyjnie rozumiany jako „pełen miłości” może mu rzeczywiście zaszkodzić. Jest to tym trudniejsze, że rynek produktów segmentu pet food dynamicznie rośnie, dotyczy to zarówno wyboru karm, jak i przysmaków. Trendy w tym sektorze odpowiadają trendom żywności ludzkiej. Mamy produkty „human grade”, premiumizację, żywienie personalizowane czy dania typu „obiadowego” – żeby mieć poczucie dzielenia się posiłkiem i dawania tego, co najlepsze dla pupila. Ten wzrost dostępności i różnorodności oferty kulinarnej dla zwierząt paradoksalnie przyczynił się do pogłębienia problemu otyłości – gdy zwierzęta mają dostęp do różnorodnych, pełnoporcjowych posiłków, a opiekunowie są motywowani uczuciami i podają zbyt duże porcje, wynik jest oczywisty: pupil przybiera na wadze. Kolejnym aspektem humanizacji jest zjawisko tzw. żywienia do woli (ang. free-feeding) – pozostawiania posiłku dostępnego dla zwierzęcia, zwłaszcza psa, przez cały dzień. Praktyka ta przejawiła się jako wynik przeniesienia sposobów myślenia o karmieniu ludzi na zwierzęta – idea, że zwierzę „wie, kiedy ma dość” lub że „powinno mieć dostęp do jedzenia na życzenie”. Tymczasem zwierzęta domowe nie posiadają naturalnych mechanizmów regulacyjnych dla porcji posiłków w środowisku pełnym wysokokalorycznych pokarmów. Gdy wrócimy do teorii „dzikich przodków”, to wiemy, że drapieżniki nie miały stałego dostępu do jedzenia. A teraz nie dość, że miska bywa stale pełna, to jeszcze dbamy, żeby jedzenie było atrakcyjne smakowo i zapachowo – bo nasze zwierzęta mają mieć przyjemność z jedzenia – podobnie jak ludzie. Badanie opublikowane w „Animals” (2023) wskazuje, że 70% opiekunów kotów i 65% opiekunów psów podaje swoim pupilom przekąski codziennie, często przekraczając dzienne zapotrzebowanie kaloryczne nawet o 30%.
Współczesna wiedza naukowa wskazuje na to, że otyłość jest znacznie bardziej złożonym zaburzeniem metabolicznym i genetycznym, a nie tylko prostym bilansem kalorycznym. Genetyka odgrywa znaczącą rolę w predyspozycji do otyłości – badania wykazały, że np. ludzie z dwiema kopiami genu FTO (fat mass and obesity associated gene) średnio ważą o 3–4 kg więcej i mają 1,67-krotnie większe ryzyko otyłości. Podobne geny mogą być identyfikowane u zwierząt domowych, co sugeruje, że niektóre rasy mogą być genetycznie predysponowane do przybierania na wadze bardziej niż inne. Jako przykład można podać gen POMC u labradorów. Nowe badania genetyczne naukowców z Cambridge pokazują, że około jedna czwarta psów rasy labrador retriever doświadcza uczucia ciągłego głodu, któremu towarzyszy spalanie mniejszej ilości kalorii z powodu mutacji genetycznej. Prowadzi to do często obserwowanej u labradorów otyłości, przez co ich opiekunowie muszą restrykcyjnie dbać o psią dietę i aktywność fizyczną podopiecznych. Mutacja występuje w genie POMC i wykryto ją u ok. 25% labradorów i 66% flat coated retriverów. Oprócz utrzymującego się uczucia głodu między posiłkami stwierdzono, że psy z mutacją POMC zużywają w spoczynku około 25% mniej energii niż psy bez tej mutacji, co oznacza, że nie muszą spożywać tak dużej liczby kalorii, aby utrzymać prawidłową masę ciała. Mutacja w genie POMC u psów zapobiega wytwarzaniu dwóch przekaźników chemicznych w mózgu psa, hormonu stymulującego beta-melanocyty (β-MSH) i beta-endorfiny, ale nie wpływa na produkcję trzeciego hormonu stymulującego alfa-melanocyty (α -MSH).
Co ciekawe, gen POMC i szlak mózgowy, na który wpływa, są podobne u psów i ludzi. Nowe odkrycia są spójne z doniesieniami o uczuciu ekstremalnego głodu u ludzi z mutacjami POMC, którzy mają tendencję do otyłości w młodym wieku i w rezultacie rozwijają wiele problemów klinicznych. Projekt „GOAT” (Genetics of Obesity in Animals Team) identyfikuje geny związane z otyłością u psów (m.in. gen POMC u labradorów). Dzięki temu możliwe będzie opracowanie testów DNA predysponujących do otyłości i spersonalizowanych zaleceń żywieniowych. Również polscy naukowcy
z UP w Poznaniu prowadzą badania nad genetycznymi uwarunkowaniami otyłości u psów.
Co jeszcze ważniejsze, naukowcy odkryli, że otyłość nie jest po prostu rezultatem „pasywnej akumulacji nadmiaru masy tłuszczowej”, lecz zaburzeniem systemu homeostazy energetycznej całego organizmu. Mózg zwierzęcia (i człowieka) posiada mechanizm dla regulacji masy ciała. Zmiany mogą wynikać z zaburzenia w wydzielaniu hormonów, w tym leptyny i greliny. Leptyna jest hormonem produkowanym przez tkankę tłuszczową, który komunikuje się z mózgiem, sygnalizując sytość; grelina zaś pobudza apetyt. W przypadku otyłości dochodzi do zjawiska zwanego „leptin resistance” – mózg przestaje prawidłowo reagować na sygnały leptyny, co prowadzi do bezustannego uczucia głodu nawet przy znacznym całkowitym spożyciu kalorii. Również badania nad adiponektyną – białkiem wydzielanym przez komórki tłuszczowe – wykazały różnice w poziomach tego białka między różnymi zwierzętami. Zwierzęta obciążone otyłością wykazują zaburzenia w ekspresji genów związanych z metabolizmem lipidów, stanami zapalnymi i zmianami we wrażliwości na insulinę. Te zmiany genetyczne i metaboliczne nie mogą być odwrócone poprzez samo zmniejszenie porcji żywieniowej – zaburzenia endokrynologiczne wymagają integracyjnego podejścia terapeutycznego, w tym często farmakoterapii.
Ostatnie lata przyniosły znaczące postępy w badaniach nad genetycznymi podstawami otyłości zarówno u ludzi, jak i zwierząt. Międzynarodowe projekty sekwencjonowania genomów zidentyfikowały ponad 41 loci w ludzkim genomie związanych z otyłością, a podobne badania prowadzi się w przypadku zwierząt domowych. Przełomowe odkrycia dotyczą nie tylko genów regulujących apetyt i metabolizm, lecz także genów odpowiadających za wydzielanie hormonów i neuromodulatorów wpływających na behawioralne aspekty żywienia. Ponieważ psy są uznawane za dobry model badawczy dla schorzeń u ludzi, to naukowcy zbadali potencjał leczenia otyłości za pomocą tych samych podejść farmakologicznych, które okazały się skuteczne u ludzi. Szczególnie obiecujące są badania nad receptorami GLP1 (glucagon-like peptide-1). GLP-1 to hormon naturalnie produkowany przez organizm w jelicie, który zwiększając ilość insuliny uwalnianej przez trzustkę, reguluje poziom cukru we krwi, opóźnia opróżnianie żołądka i zmniejsza apetyt poprzez bezpośrednie działanie na mózg. Leki imitujące działanie GLP-1, agoniści, jak semaglutyd i tirzepatyd (działa na receptor GLP-1 i GIP), wykazały spektakularne wyniki w leczeniu otyłości u ludzi,


Ekspert ds. żywienia BRIT

Otyłość to dziś jedno z najpoważniejszych zagrożeń zdrowia zwierząt towarzyszących. Prowadzi do zaburzeń metabolicznych, problemów ortopedycznych i skrócenia życia. Trend humanizacji sprawia, że opiekunowie coraz częściej „karmią emocje” zwierząt, zamiast zaspokajać ich rzeczywiste potrzeby. Diety typu light czy low calorie mają obniżoną gęstość energetyczną, wysoki poziom białka i błonnika, co pozwala redukować masę ciała bez utraty mięśni. Skutecznym wsparciem są również przysmaki o niskiej kaloryczności oraz aktywizacja poprzez zabawki węchowe czy karmienie interaktywne. W terapii otyłości doskonale sprawdza się Brit Veterinary Diet Obesity – karma opracowana do bezpiecznego, kontrolowanego odchudzania, z wysoką zawartością białka, L-karnityną i błonnikiem, wspierająca redukcję tkanki tłuszczowej i poprawę kondycji.
ze średnim zmniejszeniem masy ciała na poziomie 10% do 22% w zależności od dawki. Zainteresowanie wykorzystaniem tych terapii u zwierząt domowych rośnie zarówno w środowisku badawczym, jak i klinicznym. Badania wstępne sugerują, że GLP-1 agonisty mogą być równie skuteczne u psów i kotów, przynajmniej teoretycznie – receptory GLP-1 obecne są u wszystkich ssaków, w tym u zwierząt domowych. Jednak wdrażanie takich terapii w weterynarii napotyka na wiele wyzwań praktycznych: brak czystych preparatów dopuszczonych dla zwierząt, problemy z dawkowaniem dla różnych gatunków i rozmiarów zwierząt, potencjalne działania niepożądane specyficzne dla każdego zwierzęcia oraz – co nie jest bez znaczenia – koszt takich terapii. Oprócz GLP-1 agonistów badacze eksplorują również możliwości wykorzystania zaawansowanych technologii, takich jak implanty podskórne uwalniające hormony antyotyłościowe. Koncepcja jest zbliżona do używanych już implantów antykoncepcyjnych u ludzi – długotrwałe uwalnianie substancji czynnych mogłoby utrzymać stały poziom hormonów regulujących metabolizm bez konieczności codziennego podawania leków. Badania w tej dziedzinie są jednak wciąż we wczesnych stadiach dla zwierząt domowych. Firma Okava przygotowała podskórny implant z egzenatydem (OKV-119), projektowany specjalnie dla kotów, z uwalnianiem liczonym w tygodniach, a nawet miesiącach. Badania pokazały stabilną ekspozycję leku i utrzymywaną u większości kotów ≥ 5% redukcję masy podczas obserwacji. Inne badania skupiają się na beta glukanie. To naturalny polisacharyd występujący w ścianie komórkowej drożdży, niektórych bakterii oraz grzybów. Beta glukan izolowany z drożdży (np. S. cerevisiae) ma znane właściwości wspierające odporność nieswoistą i zdrowie skóry. Obecnie coraz liczniejsze badania wskazują, że beta glukan może być pomocny także w walce z otyłością u psów. Otyłość może prowadzić do insulinooporności, a dodatek beta glukanu w diecie obniża poziom glukozy we krwi, obniża poziom cholesterolu, a podwyższa poziom hormonu regulującego apetyt GLP-1.
Gorący obecnie temat mikrobiomu jelitowego też wiąże się z otyłością. Na przykład naukowcy z Ohio State University przeanalizowali próbki kału grubych kotów w czasie czterech zmian w diecie, w tym w okresie ści -

słej redukcji kalorii. Pod wpływem tych zmian zwierzęta traciły na wadze lub utrzymywały ją na stałym poziomie. Związane z jedzeniem zmiany w mikrobiomie jelitowym kotów – zestawie bakterii i cząsteczek wytwarzanych i spożywanych przez te bakterie – wykazują uderzające podobieństwo z wpływem diety na jelita obserwowanym wcześniej u ludzi.
Programy zwalczania otyłości
Zwalczanie epidemii otyłości wśród zwierząt domowych wymaga opracowania kompleksowych programów edukacyjnych i interwencyjnych na poziomie profesjonalistów (lekarze weterynarii, dietetycy zwierzęcy), doradców w sklepach zoologicznych i opiekunów. 24 października obchodzony jest Światowy Dzień Walki z Otyłością, stąd często październik jest też miesiącem kampanii walki z otyłością u zwierząt.
Fundamentem każdego programu jest właściwa diagnoza – lekarz weterynarii musi ocenić nie tylko obecną wagę zwierzęcia, lecz także jego Body Condition Score (BCS) – wykonać wizualną i palpacyjną ocenę ilości tkanki tłuszczowej. Konieczne jest przeprowadzenie kompleksowych badań krwi w celu oceny metabolicznych skutków otyłości. Strategia utraty masy u zwierząt różni się zasadniczo od człowieka. Podczas gdy ludzie mogą agresywnie ograniczać kalorie bez znaczących konsekwencji, u kotów tempo utraty masy powinno wynosić zaledwie 0,5–2% masy ciała miesięcznie, podczas gdy u psów można bardziej agresywnie celować w 1–3% miesięcznie. To wolne tempo oznacza, że program utraty masy u zwierzęcia to długotrwały proces, który wymaga ogromnej cierpliwości i konsekwencji od opiekuna. Warto posiłkować się dietoterapią – najbardziej skuteczne diety zawierają wyższe poziomy białka, aby zachować masę mięśniową, podczas gdy zmniejsza się masa tłuszczowa, większą zawartość włókna w celu promowania sytości bez dodatkowych kalorii i zmniejszoną zawartość tłuszczu i węglowodanów. Oprócz zmian dietetycznych program musi obejmować zwiększenie aktywności fizycznej. Dla psów może to oznaczać wydłużone spacery, dodatkowe sesje zabawy lub nawet pływanie (które jest szczególnie korzystne dla psów z problemami stawowymi). W przypadku kotów, które naturalnie są mniej skłonne do aktywności na życzenie opiekuna, może to wymagać
bardziej kreatywnego podejścia – interaktywne zabawki, gry łowieckie czy zainstalowanie mebli do wspinania.
Paradoksalnie zrozumienie psychologicznych motywacji stojących za humanizacją zwierząt może być kluczem do rozwiązania problemu otyłości lepszym niż tradycyjne podejście polegające na zakazach. Zamiast krytykowania opiekuna za karmienie zwierzęcia profesjonaliści powinni pomóc w zredefiniowaniu, co oznacza „miłość” w kontekście żywienia zwierzęcia. Nowe kampanie edukacyjne zaczynają promować ideę, że prawdziwa miłość do zwierzęcia oznacza zapewnienie mu długiego, zdrowego i aktywnego życia – co jest możliwe tylko poprzez prawidłowe żywienie, a nie poprzez karmienie do woli. Idea „jeśli kocham moje zwierzę, muszę je nagradzać jedzeniem” jest zastępowana koncepcją, że „jeśli kocham moje zwierzę, muszę zadbać o jego długoterminowe zdrowie, nawet jeśli oznacza to ograniczenie ilości jedzenia, które mu daję”.
Stanowi to też wyzwanie dla doradców w sklepach. W erze humanizacji zwierząt doradcy pracujący w sklepach zoologicznych znajdują się w unikalnej pozycji –stanowią pierwszą linię kontaktu dla wielu opiekunów zwierząt. Ich poziom wyszkolenia powinien pozwolić na profesjonalny dobór karmy na podstawie oceny potrzeb danego zwierzęcia na podstawie wywiadu z opiekunem. Doradcy powinni być w stanie wyjaśnić opiekunom, jak ocenić, czy ich zwierzę jest w idealnej kondycji. Szczególnie ważne jest szkolenie w umiejętnościach komunikacyjnych – jak wyjaśnić opiekunowi, że jego mały, otyły pies jest w rzeczywistości zagrożony zdrowotnie, bez przywołania defensywności lub poczucia winy. Wizualne pomoce, łącznie z zdjęciami i diagramami, powinny być dostępne w sklepach. Zamiast karmienia do woli doradcy powinni promować porcje mierzone dokładnie zgodnie z zaleceniami producenta. Opiekunom może też pomagać technologia – np. inteligentne dozowniki karmy (ang. smart feeders, miseczki IoT) czy obroże z monitoringiem stanu zdrowia pupila. Należy podkreślać, że smaczki trzeba limitować i wliczać je do planu dziennego spożywanych kalorii. Ponadto, zamiast nieustannego oferowania przysmaków, doradcy mogą promować nieżywieniowe formy nagradzania zwierząt: zabawki interaktywne, sesje zabaw itp. Profesjonalni doradcy powinni zachęcać opiekunów do konsultacji z lekarzem weterynarii przed podjęciem drastycznych zmian w diecie, ale także do regularnych wizyt profilaktycznych. Mogą także oferować „konsultacje żywieniowe” we współpracy z dietetykami zwierzęcymi. W ofercie sklepu są też suplementy wspomagające walkę z otyłością (z substancjami aktywnymi, jak L-karnityna, koenzym Q10, ekstrakt z zielonej herbaty, pre-,pro- i postbiotyki, psyllium, beta glukan).
Wnioski – przemiany społeczne jako szansa dla biznesu i zdrowia
Epidemia otyłości wśród zwierząt domowych jest ostatecznie wynikiem naszej rosnącej miłości do nich. Fakt, że traktujemy zwierzęta jako pełnoprawnych członków rodziny, jest pozytywnym krokiem dla dobrostanu zwierząt – oznacza to na ogół lepszą opiekę, dostęp do opieki weterynaryjnej i mniej zaniedbań. Problemem nie
jest sama humanizacja, lecz jej niewłaściwe wyrażenie poprzez nadmierne karmienie i ignorowanie naturalnych potrzeb zwierząt. Zwrot w kierunku świadomego, opartego na faktach podejścia do żywienia zwierząt już się dzieje. Producenci karm inwestują w naukowe opracowywanie diet. A coraz więcej opiekunów, szczególnie w pokoleniach młodszych, wykazuje gotowość do zaakceptowania, że ograniczenie przysmaków na rzecz zdrowia długoterminowego jest obecnie optymalnym wyborem dla ich zwierząt. Dla profesjonalistów pracujących w branży pet care zrozumienie kompleksowej relacji między otyłością a chorobami przewlekłymi jest absolutnie niezbędne do edukacji opiekunów zwierząt i promowania proaktywnych interwencji zdrowotnych.
Literatura:
• „Journal of Veterinary Internal Medicine” (2024): Obesity in Dogs: Prevalence and Risk Factors.
• Montoya M., Péron F., Hookey T., Morrison J., German A.J., Gaillard V., Flanagan J., Overweight and obese body condition in ~4.9 million dogs and ~1.3 million cats seen at primary practices across the USA: Prevalences by life stage from early growth to senior, Preventive Veterinary Medicine, 2025, https://doi.org/10.1016/j.prevetmed.2024.106398.
• Science Advances , 2024; 10 (10) DOI: 10.1126/sciadv.adj3823.
• Scientific Reports volume 14, Article number: 11901 (2024).
• „Animals” (2023): Humanization of Pets and Its Impact on Their Diet
• Biology (Basel) 2024 doi: 10.3390/biology13050335.
• WSAVA Guidelines on Obesity Prevention.


Najnowsze trendy, analizy konsumenckie i gotowe pomysły sprzedażowe dla sklepów zoologicznych
Święta to moment magii nie tylko dla ludzi, lecz także dla naszych futrzastych przyjaciół. Coraz więcej opiekunów psów i kotów traktuje swoje zwierzęta jak pełnoprawnych członków rodziny – w ostatnich latach obserwujemy stały wzrost trendu humanizacji zwierząt. A pod choinką nie brakuje też prezentów dla „psiecka” i „kociecka”. Dane z rynków światowych wskazują, że spora grupa opiekunów planuje kupić prezent dla psa lub kota w okresie świątecznym. Rosną segmenty premium, personalizowane, ekologiczne i technologiczne. Dla właścicieli sklepów zoologicznych to kluczowy sezon sprzedażowy, a zrozumienie trendów i potrzeb konsumentów może przynieść znaczące korzyści.
Kategoria karm i smakołyków pozostaje królem świątecznych zakupów: kalendarze adwentowe, limitowane przysmaki i zestawy prezentowe
z jedzeniem to produkty łatwe do sprzedaży i pakowania.
Co mówią badania konsumenckie?
Raport Pet Care Industry Trends & Statistics for 2025 wskazuje, że ponad połowa opiekunów (51%) deklaruje, że ich zwierzęta są częścią rodziny jak ludzie. Według badań Talker Research dla Vetster 48% Gen Z w USA nie widzi różnicy między dzieckiem a pupilem. Ponadto rośnie liczba gospodarstw wielozwierzęcych wśród młodych dorosłych: według tych samych źródeł 70% opiekunów z Gen Z ma dwa lub więcej zwierząt. Trend kupowania zwierzętom prezentów na święta pozostaje silny. Według badań ankietowych przeprowadzonych w 2022 roku ponad 80% opiekunów deklarowało bardzo duże prawdopodobieństwo kupienia czegoś dla podopiecznych, a ponad 50% zadeklarowało, że wyda na prezenty dla zwierzaka więcej niż na niektórych członków rodziny! Mimo zawirowań ekonomicznych z aktualnych badań (PR Newswire Package Facts) wynika, że 70% opiekunów psów i kotów w USA kupuje prezenty dla swoich zwierząt podczas Bożego Narodzenia, według ankiety z 2023 z innego źródła (Circana) jest to ponad 50% opiekunów. Co więcej, młodsze pokolenia (Millenialsi i Gen Z) znacznie częściej kupują prezenty interaktywne, akcesoria i zabawki – co otwiera przestrzeń na produkty premium i technologiczne. Według Weenect Christmas Study z lat 2023–2024 (respondentami byli w 60% opiekunowie psów, a w 40% opiekunowie kotów z Francji, Niemiec,
Belgii, Szwajcarii i Austrii) w 2024 roku 76,9% opiekunów zwierząt planowało podarować swojemu pupilowi prezent na święta Bożego Narodzenia (w 2023 roku odsetek ten wynosił 82,5%). Ten niewielki spadek może odzwierciedlać trudniejszą sytuację ekonomiczną lub rosnące zainteresowanie bardziej odpowiedzialną konsumpcją. Psy są nieco bardziej rozpieszczane niż koty. Nieco więcej opiekunów psów (80,4%) niż kotów (74,1%) podtrzymuje świąteczną tradycję. Dla 74,4% opiekunów obdarowywanie zwierząt prezentami świątecznymi jest tradycją, która rozpoczęła się już w momencie adopcji. W 2024 roku 66,5% opiekunów wybierało prezenty na podstawie upodobań swojego pupila, podczas gdy w 2023 roku było to 59,5%, co wskazuje na rosnącą potrzebę personalizacji podarunków. Drugorzędne znaczenie miały: poszukiwania online (15,2%) oraz cena (11,5%).
Z badania Weenect wynika, że dla 44,8% opiekunów zwierzę jest pełnoprawnym członkiem rodziny, co motywuje ich do wręczania prezentów. Na drugim miejscu znajduje się chęć sprawienia pupilowi radości (39,1%), a na trzecim sama świąteczna tradycja (15,2%) – trend ten pozostaje stabilny w porównaniu z 2023 rokiem. Kategoria karm i smakołyków pozostaje królem świątecznych zakupów: kalendarze adwentowe, limitowane przysmaki i zestawy prezentowe z jedzeniem to produkty łatwe

Badanie psychologii konsumentów przeprowadzone w 2025 roku przez
Uniwersytet w Melbourne wykazało, że dodanie imienia lub sylwetki zwierzęcia domowego do przedmiotów codziennego użytku powoduje 28-procentowy wzrost wydzielania oksytocyny u opiekuna, zasadniczo
zmieniając prozaiczne przedmioty w emocjonalne punkty styku.
do sprzedaży i pakowania. Popularność smakołyków znacznie wzrosła w porównaniu z rokiem 2023. Również raport Circana oraz inne raporty branżowe wielokrotnie potwierdzają, że jedzenie/ przysmaki są najczęściej kupowanymi prezentami dla pupili. Według Weenect Psy otrzymują głównie zabawki (39,2%) i smakołyki (36,3%), podczas gdy koty otrzymują praktyczne przedmioty, takie jak legowiska (17,3%), a także zabawki (37,8%). Jednak w innych raportach praktyczne przedmioty zajmują trzecie miejsce, po jedzeniu i zabawkach – można to uznać za przeniesienie założeń prezentowych dla ludzi, wszak w mniemaniu wielu osób dawanie praktycznych prezentów odbiera element uczuciowy.
Co ciekawe, według raportu „Holiday Spending on Pets Soars” australijskie firmy pet-retail zauważają znaczny wzrost sprzedaży w okresie świątecznym: nie tylko smakołyki i zabawki, ale i usługi (np. groomingu) cieszą się popytem. Z badania Real Insurance wynika, że blisko 59,6% Australijczyków planuje kupić w święta prezent dla swojego zwierzęcia, zaś 89% opiekunów nazywa siebie „mamą” i „tatą” pupila. Wśród planowanych zakupów są zabawki (79,1% respondentów), legowiska (21,1%), smakołyki (19,8%), ubrania i akcesoria (18,0%) oraz pakiety pielęgnacyjne (13,3%). Rynek australijski cechuje wysoki poziom wydatków na zwierzęta – w danych branżowych wskazywano wzrost wydatków na poziomie miliardów dolarów australijskich rocznie, co potwierdza rosnące znaczenie segmentu „pet” w tym kraju i popyt na produkty premium oraz usługi (np. grooming, „pet-resorts”, subskrypcje żywieniowe).
Kluczowe trendy w branży pet na sezon prezentowy
Na podstawie najnowszych raportów z branży (m.in. Global Pet Expo 2025, raporty trendów) można wyodrębnić kilka obszarów, które szczególnie dobrze sprawdzą się jako kategoria świątecznych prezentów. Niżej najważniejsze z nich:
Pet Tech i Smart Care Rosnący rynek urządzeń technologicznych dla zwierząt to nie tylko gadżety – to coraz bardziej narzędzia zdrowotne. Wśród najczęściej przewidywanych kategorii są: obroże GPS, trackery aktywności, inteligentne karmniki, automatyczne kuwety, które ułatwiają opiekę zapracowanym ludziom. Inteligentne karmniki, trackery aktywności, fontanny filtrujące i automatyczne kuwety to kategorie coraz częściej wybierane jako prezenty z wyższej półki – zarówno w USA, jak i Australii. Trend ten jest napędzany potrzebą wygody opiekuna i chęcią monitorowania zdrowia pupila. W Australii technologie związane z karmieniem i monitoringiem zwierząt stają się coraz bardziej powszechne, urządzenia typu smart wykazują trend rosnący.
Zabawki interaktywne, stymulujące i wzbogacanie środowiska
Zabawki na myślenie, maty węchowe, zabawki do napełniania jedzeniem, ruchome zabawki dla kotów –wszystko, co wiąże się z angażowaniem zmysłów, „mądrym” zmęczeniem zwierzęcia, a także wzbogacaniem środowiska i urozmaicaniem czasu, także gdy opiekuna nie ma w domu. Wpisuje się to w trend świadomej opie -

ki i zapewniania dobrostanu zwierzęcia, umożliwienia mu realizacji potrzeb gatunkowych (np. węszenia dla psa, pościgu za zdobyczą u kota).
Zabawki „edukacyjne” to świetny pomysł świąteczny – dają opiekunom poczucie, że inwestują oni w rozwój i dobrostan pupila. Global Pet Expo wskazywał, że to kluczowy trend w 2025 roku.
Wellness i pielęgnacja
Tutaj możemy wymienić naturalne kosmetyki, balsamy do łap i nosków, suplementy funkcjonalne czy zestawy poprawiające jakość sierści. Produkty pielęgnacyjne o naturalnych składach, zestawy spa dla zwierząt, suplementy funkcjonalne i zabiegi groomingu (vouchery) cieszą się rosnącym zainteresowaniem – opiekunowie szukają prezentów, które poprawią komfort i zdrowie zwierzęcia.
Co ciekawe, jest to szybko rosnący segment w Australii. Według raportu Expert Market Research w 2024 roku wartość rynku groomingowego wynosiła tam ok. 261,3 mln A$,
a prognozy przewidują CAGR 11,9% do 2034 roku. Na targach prezentowych pojawiają się marki, które łączą pielęgnację ludzi (skincare) z produktami dla zwierząt, m.in. naturalne, ręcznie robione kosmetyki dla psów. W Australii rośnie popyt na usługi premium dla zwierząt: luksusowe hotele dla psów i kotów. Tzw. pet resorty oferują pokoje de luxe, w których noc może kosztować ponad 100 A$, a w okresie świątecznym nawet więcej! W Europie zaś nadal wiodącym segmentem będą suplementy funkcjonalne.
Luksus i personalizacja
Rośnie rynek DTC (direct-to-consumer), w którym marki oferują spersonalizowane produkty, jak portrety zwierząt, personalizowane ubranka, miski czy akcesoria premium. Święta to oczywiście limitowane edycje ubranek, a nawet poduszki z pulsującym sercem… Według australijskiego przewodnika Lovepetever spersonalizowane prezenty budują silniejszą więź emocjonalną
między opiekunem a pupilem
W 2025 r. badanie zachowań konsumentów przeprowadzone przez QUT wśród 1203 australijskich opiekunów psów wykazało, że spersonalizowane przedmioty wywoływały o 43% wyższy wynik „przywiązania emocjonalnego” w sprawdzonej skali więzi między zwierzęciem a człowiekiem. Badanie psychologii konsumentów przeprowadzone w 2025 roku przez Uniwersytet w Melbourne wykazało zaś, że dodanie imienia lub sylwetki zwierzęcia domowego do przedmiotów codziennego użytku powoduje 28-procentowy wzrost wydzielania oksytocyny u opiekuna, zasadniczo zmieniając prozaiczne przedmioty w emocjonalne punkty styku.
Dane branżowe z 2025 r. wskazują na 47% wzrost sprzedaży niestandardowych produktów dla zwierząt domowych w porównaniu z rokiem poprzednim, ponieważ opiekunowie poszukują znaczących sposobów na uczczenie swoich czworonożnych członków rodziny.





Ekologia, recykling i świadomość prośrodowiskowa opiekunów
Produkty „clean-label” (czyste składy), ekologiczne biodegradowalne opakowania i certyfikaty zrównoważenia są coraz częściej decydującym czynnikiem zakupu, zwłaszcza młodszych pokoleń. Wynika to choćby z raportu Pet Care Industry (PCI Trends & Statistics for 2025), w którym około 70% opiekunów zwierząt deklaruje, że stara się robić zakupy bardziej ekologicznie – wybierają produkty z recyklingu, biodegradowalne opakowania czy lokalne marki.
Zatem warto pomyśleć o ofercie z segmentu eco-prezentów, np. zabawek z recyklingowanych materiałów. Konsumenci coraz częściej wybierają prezenty w sposób świadomy, Weenect podkreśla, że rośnie znaczenie zrównoważonych wyborów, takich jak produkty używane z drugiej ręki („pre-loved”), co u nas jeszcze nie jest bardzo zakorzenione. Ale widzimy ten trend w produktach dla ludzi, np. w odniesieniu do odzieży.
Bezpieczeństwo i etyka – ważne elementy świątecznej komunikacji
Choć prezenty dla zwierząt to rosnący trend, pojawiają się też zagrożenia dla pupila. Stąd jeszcze raz podkreślamy istotną rolę doradcy w sklepach – bo to oni wyjaśnią, dlaczego warto kupić smaczki dla zwierząt, a nie karmić ze stołu, pomogą dobrać odpowiednie ubranko – funkcjonalne, niekrępujące ruchów i przestrzegą przed nieodpowiednimi dla zwierząt zabawkami, które mogą zawierać elementy toksyczne lub ruchome, łatwe do połknięcia. Jest tu też miejsce na przypomnienie, które
produkty żywnościowe szkodzą pupilowi. Warto zawsze w alternatywie zaproponować limitowane, świąteczne smaki produktów dla zwierząt. Sklepy powinny też się włączyć w kampanie edukacyjne, że zwierzę to nie prezent, tylko odpowiedzialność na lata. Jak przygotować sklep zoologiczny na święta?
Uczymy się od innych branż. Wiele sklepów ma już wydzielone strefy prezentowe. Używa świątecznej kolorystyki: czerwieni, zieleni, złota. Warto wykorzystać media społecznościowe jako kluczowe w kontaktach z klientem – organizować konkursy, pokazywać pomysły na prezenty i dbać o inspirujące treści. Wzorem budowania atmosfery oczekiwania na święta można oferować kalendarze adwentowe, tworzyć zestawy prezentowe do strefy przykasowej i oferować limitowane świąteczne edycje produktów. Gift boksy tematyczne (np. dla seniorów, eco) to też ciekawy pomysł. Dodanie rodzinnych emocji obdarowującemu to opcja pakowania na prezent lub zestawy DIY do samodzielnego pakowania w domu. Święta to też idealny moment, by zwiększyć bazę stałych klientów –każdy zakup świąteczny może dawać dodatkowe punkty, rabaty lub drobne upominki.
Święta to ogromna szansa dla sklepów zoologicznych – warto rozwijać segment prezentów, łączyć trendy z edukacją klientów i budować lojalność poprzez dobrze przemyślane świąteczne kolekcje. Pomoże to zamienić grudzień w najbardziej dochodowy miesiąc roku.



Jak mikrobiom jelitowy wpływa na zachowanie psa?

Tekst: Adrianna Iwan
Mikrobiom jelitowy to złożony, specyficzny i unikatowy dla każdego zwierzęcia ekosystem. Odgrywa kluczową rolę w utrzymaniu dobrego zdrowia i samopoczucia. Charakteryzuje się on najliczniejszą i najbogatszą liczebnością gatunków. W skład mikrobiomu jelitowego wchodzą wirusy, bakterie, grzyby, archeony, z czego większość stanowią bakterie. Dysbioza, czyli zachwianie równowagi w mikrobiomie jelitowym, może prowadzić do problemów zdrowotnych, m.in. zmian w zachowaniu. Zaburzenia behawioralne u psów stanowią coraz większe wyzwanie dla opiekunów i lekarzy weterynarii. Są one często powodem porzucania tych zwierząt. Ostatnie badania sugerują, że istnieje korelacja między składem mikrobioty a regulacją psychologiczną i behawioralną u zwierząt. Istnieją dowody, że skład mikrobioty jelitowej stymuluje oś jelitowo-mózgową (HPA), przez co wpływa ona na zmianę zachowań oraz poziom agresji.
Skład mikrobiomu jelitowego różni się w zależności od lokalizacji w przewodzie pokarmowym. Każdy odcinek charakteryzuje się unikalnymi
warunkami środowiskowymi, dlatego liczba bakterii i skład gatunkowy będą się różniły w zależności od odcinka przewodu pokarmowego.
Skład i rola mikrobiomu jelitowego
Dominujące typy bakterii to: Firmicutes, Bacteroidetes, Actinobacteria, Fusobacteria oraz Proteobacteria. Skład mikrobiomu jelitowego różni się w zależności od lokalizacji w przewodzie pokarmowym. Każdy odcinek charakteryzuje się unikalnymi warunkami środowiskowymi, dlatego liczba bakterii i skład gatunkowy będą się różniły w zależności od odcinka przewodu pokarmowego. W dwunastnicy przeważają bakterie Firmicutes, Proteobacteria i Fusobacteria. W jelicie czczym dominującymi typami są Proteobacteria, Spirochaetes i Fusobacteria. Z kolei w jelicie krętym dominują Firmicutes, Tenericutes, Proteobacteria
Mikrobiom końcowych odcinków jelit składa się głównie z Firmicutes (najliczniejszy), Bacteroidetes, Actinobacteria, Fusobacteria i Proteobacteria
Mikrobiom jelitowy to jeden z najważniejszych czynników, od których zależy zdrowie psa. Wśród podstawowych funkcji mikrobiomu jelitowego wymienia się:
• produkcję krótkołańcuchowych kwasów tłuszczowych (SCFA), które dostarczają energii komórkom nabłonka jelitowego,
• metabolizm kwasów żółciowych,
• ochronę przewodu pokarmowego przed wzrostem mikroorganizmów patogennych,
• stymulację układu immunologicznego poprzez aktywację tkanki limfatycznej, która jest związana z błoną śluzową przewodu pokarmowego (GALT),


• produkcję bakteriocyn, które mają działanie bakteriobójcze lub bakteriostatyczne na mikroorganizmy patogenne,
• rolę w syntezie witamin, głównie z grupy B oraz witaminy K i enzymów,
• regulację metabolizmu glukozy i lipidów,
• wpływ na zachowanie i zdrowie psychiczne poprzez oś jelitowo-mózgową (oddziaływanie na syntezę neuroprzekaźników).
Oś jelito – mózg
Termin „oś jelito – mózg” odnosi się do dwukierunkowej biochemicznej komunikacji między przewodem pokarmowym a mózgiem. Komunikacja ta odbywa się za pośrednictwem jelitowego układu nerwowego i nerwu błędnego, współczulnego układu nerwowego, osi podwzgórze – przysadka – nadnercze, układu odpornościowego oraz metabolitów drobnoustrojów. Komórki nerwowe, które budują jelitowy układ nerwowy (ENS – enteric nervous system), tworzą drugie największe skupisko neuronów w organizmie, które często jest nazywane jelitowym mózgiem. Kluczową rolę odgrywa tu nerw błędny, ponieważ komórki nerwowe komunikują się z ośrodkowym układem nerwowym właśnie za jego pośrednictwem. Bakterie są zdolne do wytwarzania substancji neuroaktywnych, w tym prekursorów neurotransmiterów, które mogą oddziaływać na oś jelitowo-mózgową, a w konsekwencji na układ nerwowy. Mikrobiota

Postbiotyk dla psów i kotów
Zdrowy mikrobiom
Lepsze trawienie
Wsparcie odporności
Prawidłowe nawodnienie
Redukcja kamienia nazębnego
Szybsze gojenie ran
Zdrowa skóra, lśniąca sierść
EFEKT 10 DNIACH już po *



Maciej Reimus
Product Manager
BIOFEED


Coraz więcej badań potwierdza, że mikrobiom jelitowy ma kluczowy wpływ nie tylko na zdrowie układu pokarmowego, lecz także na funkcjonowanie układu nerwowego i zachowanie zwierząt. Mówimy tu o tzw. osi jelito–mózg – dwukierunkowym systemie komunikacji pomiędzy przewodem pokarmowym a centralnym układem nerwowym.
Mikrobiota jelitowa wzmacnia integralność bariery jelitowej, zapobiegając translokacji toksyn i endotoksyn do krwiobiegu, które mogą pobudzać ośrodkowy układ nerwowy i prowadzić do zaburzeń zachowania.
Prawidłowy mikrobiom jelitowy można wspierać poprzez zbilansowaną dietę bogatą w błonnik prebiotyczny – np. fruktooligosacharydy (FOS), mannanooligosacharydy (MOS), dostarczanie fermentowanych składników i drożdży wspierających rozwój korzystnych bakterii, unikanie białka zwierzęcego o niskiej strawności, które może zaburzać mikroflorę. Wprowadzając stałe pory karmienia i ograniczenie stresu, które również wpływają na stabilność mikrobioty.
Równie ważną rolę odgrywają postbiotyki, to nieżywe mikroorganizmy lub ich metabolity, które mimo braku zdolności do namnażania wywierają korzystny wpływ na organizm. W linii Euphoria Fresh postbiotykiem, który wykorzystujemy jest inaktywowany szczep Lactobacillus paracasei, który wspiera barierę jelitową, wpływa na modulację odpowiedzi immunologicznej oraz redukuje stany zapalne.
Dokładne mechanizmy, poprzez które mikrobiota jelitowa moduluje zdrowie
psychiczne, nie zostały jeszcze w pełni poznane.
jelitowa może zakłócać mechanizmy neuronalne poprzez regulację poziomu neuroprzekaźników, w tym serotoniny (5-HT), dopaminy, noradrenaliny i kwasu gamma-aminomasłowego. Może pośrednio lub bezpośrednio wpływać na szlaki metaboliczne tryptofanu, prowadząc do produkcji serotoniny, zwłaszcza szczepy Escherichia, Streptococcus i Enterococcus. W regulacji dopamainy znaczącą rolę odgrywają bakterie z rodzaju Bacillus. Z kolei przykładami bakterii produkujących noradrenalinę są Escherichia i Bacillus. W przypadku GABA jego źródłami są bakterie L actobacillus, Leuconostoc, Enterococcus, Propionibacterium, Pediococcus
Dokładne mechanizmy, poprzez które mikrobiota jelitowa moduluje zdrowie psychiczne, nie zostały jeszcze w pełni poznane.
Wpływ stresu na mikrobiotę jelitową
Bakterie mikrobioty jelitowej mają też zdolność do modulowania osi podwzgórze – przysadka – nadnercze. Oś ta indukuje uwalnianie kortyzolu (hormonu stresu), którego rolą jest regulowanie odpowiedzi na bodźce stresowe. Długotrwały, przewlekły stres może doprowadzić do uruchomienia kaskady reakcji biochemicznych, których efektem będzie odpowiedź immunologiczna prowadząca do zmian w składzie mikrobioty jelitowej (np. zwiększenie liczby niepożądanych drobnoustrojów z rodzaju Clostridium). Wszelkie niekorzystne zmiany składu mikrobioty mogą doprowadzić do modyfikacji reakcji na sytuacje stresowe. Przewlekły stres pobudza autonomiczny układ nerwowy, który, jak już wiadomo, jest połączony z przewodem pokarmowym (oś jelitowo-mózgowa). W ten sposób stres wpływa na mikrobiotę jelitową, moduluje ją, a to może wpływać na zmianę zachowania u zwie -
rząt. Osłabiona kondycja psychiczna zwierzęcia spowodowana długotrwałym stresem lub przewlekle odczuwanym lękiem może mieć wpływ na zmianę składu mikrobioty. Tannock i wsp. przeprowadzili badanie na myszach, w którym zwierzęta te zostały pozbawione dostępu do jedzenia, co spowodowało u nich sytuację stresową. Zaobserwowano u tych zwierząt wzrost poziomu Escherichia coli, a spadek bakterii z rodzaju Lactobacillus. Z kolei Gareau i wsp. w swoich badaniach zainfekowali szczury Cirtobacter rodentium. Wywołali sytuację stresową u tych zwierząt, uniemożliwiając im dostęp do wody. Badacze zaobserwowali ubytki w pamięci u badanych zwierząt. Ich obserwacje sugerują więc, że stres i infekcje patogenami jelitowymi mogą znacząco wpływać na układ nerwowy. Wpływ mikrobiomu jelitowego na zachowanie
Coraz więcej badań wskazuje na związek między zachowaniem z mikrobiomem jelitowym u zwierząt. W literaturze naukowej można znaleźć badania u szczurów i myszy, które dowodzą, że podawanie konkretnych szczepów probiotycznych znacząco ogranicza zachowania depresyjne i lękowe. Badania na myszach wykazały, że skład mikrobioty jelitowej ma bezpośredni związek z zachowaniami depresyjnymi. Podawanie myszom Lactobacillus rhamnosus (JB-1) spowodowało zmniejszenie reakcji lękowych. W innym badaniu na modelu mysim podawanie Bacteroides fragilis NCTC również zmniejszało nasilenie reakcji lękowych. Liang i wsp. wykazali, że Lactobacillus helveticus NS8 posiada antydepresyjne właściwości. Zespół kierowany przez Messaoudi dowiódł, że skutki przewlekłego stresu u tych zwierząt ograniczono po zastosowaniu szczepu Lactobacillus helveticus R0052 oraz Bifidobacterium longum R0175.




Hanna Kantor
Dystrybutor marki Dyrektor marketingu www.portica.pl

DeliGuard dla psów i kotów. Zdrowie jelit i nie tylko!
Polecamy Państwu postbiotyk DeliGuard – suplement, jakiego jeszcze nie było. To niezrównane wsparcie w przypadku wszelkich problemów z jelitami, trawieniem, a nawet alergiami. Skutecznością, niezawodnością i szybkością działania przewyższa, podawane zazwyczaj, probiotyki. DG zawiera unikalne substancje wytworzone przez bakterie Bacillus subtilis, np. ich metabolity czyli enzymy, kwasy organiczne, peptydy, kwasy tłuszczowe, witaminy. Dzięki wsparciu jelit oddziałuje na cały organizm zwierzęcia. Działa przeciwzapalnie, wzmacnia odporność, poprawia funkcjonowanie wątroby, reguluje nawodnienie organizmu i sprzyja higienie jamy ustnej. Wpływa na zdrowie skóry i sierści. Można go podawać w przypadku różnych problemów ze zdrowiem (patrz przewodnik!), ale też profilaktycznie przez całe życie zwierzęcia. Dzięki płynnej formie jego biodostępność jest wyższa niż w przypadku tabletek. I dużo łatwiej go podawać – z wodą lub karmą. Zapewnia szybkie rezultaty bez skutków ubocznych i przeciwwskazań.
Zamów tutaj: PORTICA, biuro@portica.pl, tel. 42 631 00 13
Producent: BioDose
Monado i wsp. wykazali w swoich badaniach, że psy lękowe miały podwyższony poziom bakterii Lactobacillus, które znane są z regulacji zachowania poprzez produkcję GABA. Obiecującym łącznikiem między behawioralnymi chorobami współistniejącymi a padaczką stała się oś jelita – mózg. Według badań psy z padaczką lekooporną mają tendencję do doświadczania częstszego lęku. Badacze z Texas A&M College of Veterinary Medicine and Biomedical Sciences oraz Center for Systems Neuroscience w Niemczech odkryli, że przeszczepy mikrobioty kałowej (FMT) mogą zmniejszyć negatywne objawy zdrowia psychicznego u psów z padaczką, zwłaszcza padaczką lekooporną. W badaniu wzięło udział dziewięć psów. Każdy z nich otrzymał FMT trzy razy w ciągu kilku tygodni. Psy po FMT były spokojniejsze i wykazywały mniejszą impulsywność. Zaobserwowano niewielkie zmiany taksonomiczne ze spadkiem bakterii Peptococcaceae, które są wiązane ze stresem i lękiem. U jednego z dziewięciu badanych psów zaobserwowano redukcję częstości napadów padaczkowych o 50%.
W przypadku zachowań agresywnych w literaturze naukowej również można znaleźć ciekawe badania. Kirchof i in. przeprowadzili badanie na 31 psach rasy american pit bull terrier i pokrewnych, które w przeszłości uczestniczyły w walkach psów. Badacze zaobserwowali, że liczba bakterii z rodzaju Bacteroides u tych psów była zdecydowanie niższa w porównaniu z psami mniej agresywnymi. Bakterie z rodzaju Dorea również były mniej liczne u psów agresywnych. Według ich wstępnych analiz mikrobiota jelitowa psów agresywnych charakteryzuje się także wyższym poziomem bakterii z rodzaju Firmicutes, Fusobacteria, Bacteroidetes. Autorzy tego badania sugerują, że wiedzę tę można będzie wykorzystać w przyszłości do oceny ryzyka agresji u tych zwierząt. Badacze zaobserwowali także, że agresja i mikrobiota są powiązane z poziomem kortyzolu oraz procesami zapalnymi. Istotny jest także w tym przypadku fakt, że bakterie wchodzące w skład mikrobioty jelitowej biorą udział

w trawieniu i wchłanianiu substancji odżywczych, dzięki czemu organizm zwierzęcia uzyskuje niezbędne składniki do syntezy neuropeptydów, m.in. tryptofanu, który jest konieczny do syntezy serotoniny. Mikrobiota jelitowa w ten sposób wpływa na zachowania związane z neurotransmisją serotoninergiczną.
Inne badania wykazują, że podawanie bakterii Bifidobacterium longum NCC 3001 psom pozwalało zredukować nasilenie i częstotliwość reakcji lękowych. Zaobserwowano także, że podawanie probiotyku zmniejszało stężenie kortyzolu w ślinie. Działanie bakterii probiotycznych było widoczne zwłaszcza u psów lękliwych. Związane jest to z faktem, że przewlekłe zapalenie przewodu pokarmowego spowodowane dysbiozą jelit może wywołać zachowania podobne do lęku, co popiera tezę wpływu mikrobioty jelitowej na układ nerwowy.
Literatura:
• Bercik P., Park A.J., Sinclair D., Khoshdel A., Lu J., Huang X., Verdu E.F. (2011). The anxiolytic effect of Bifidobacterium longum NCC3001 involves vagal pathways for gut-brain communication. Neurogastroenterology & Motility; 23(12), 1132–1139.
• Iwan A., Bełezina K. (2023). Mózg w jelitach – czy mikrobiota jelitowa może wpływać na zachowanie psów? Weterynaria w Praktyce; 4.
• Kim H. i wsp. (2025). Understanding the diversity and roles of the canine gut microbiome. Journal of Animal Science and Biotechnology; 16 (95).
• Liang S., Wang T., Hu X. i inni. Administration of Lactobacillus helveticus NS8 improves behavioral, cognitive, and biochemical aberrations caused by chronic restraint stress. Neuroscience; 2015; 310: 561–77.
• Messaoudi M., Lalonde R., Violle N. i inni. Assessment of psychotropic-like properties of a probiotic formulation (Lactobacillus helveticus R0052 and Bifidobacterium longum R0175) in rats and human subjects. Br J Nutr 2011; 105: 755–64.
• Mondo i wsp. (2020). Gut microbiome structure and adrenocortical activity in dogs with agressive and phobic behavioral disorders Heliyon; 6(1).
• Sacoor C. i wsp. (2024). Gut-brain axis impact on canine anxiety disorders: new challenges for behavioral veterinary medicine. Veterinary Medicine International.
• Watanangura A. i wsp. (2024). Behavioral comorbidities treatment by fecal microbiota transplantation in canine epilepsy: a pilot study of a novel therapeutic approach. Frotntiers in Veterinary Science; 11.


Technologia w opiece i treningu zwierząt

Tekst: Natalia Młodnicka
Trenerka, behawiorystka, dietetyk zwierzęcy nakazdalape.pl
W dzisiejszych czasach w kwestii opieki oraz treningu psów i kotów z pomocą przychodzi najnowsza technologia. W ostatnich latach obserwujemy gwałtowny wzrost zainteresowania wykorzystaniem narzędzi cyfrowych i urządzeń pomiarowych, które pozwalają nie tylko monitorować stan zdrowia zwierząt, lecz także analizować ich zachowanie, emocje i reakcje na bodźce środowiskowe. To, co jeszcze dekadę temu wydawało się odległą futurystyczną wizją, dziś jest normą. Postępująca cyfryzacja opieki nad zwierzętami domowymi zmienia sposób, w jaki człowiek sprawuje opiekę nad psem lub kotem oraz redefiniuje samą relację między gatunkami – wprowadzając do niej element precyzyjnej analizy danych, personalizacji i predykcji zachowań.
Algorytmy analizy danych potrafią wykrywać subtelne zmiany w rytmie aktywności, częstotliwości odpoczynku czy wzorcach poruszania się, które dla ludzkiego obserwatora byłyby niezauważalne.
Obecnie na rynku jest dostępnych wiele produktów określanych mianem wearables. Są to między innymi inteligentne obroże, czujniki biometryczne czy kamery analizujące ruch . Dzięki nim możliwe jest kontrolowanie aktywności fizycznej, parametrów fizjologicznych czy wzorców zachowań. Smart collars wyposażone w moduły GPS, akcelerometry i czujniki tętna pozwalają na monitorowanie poziomu aktywności psa lub kota w czasie rzeczywistym, co ma szczególne znaczenie w ocenie kondycji fizycznej, przebiegu rekonwalescencji czy skuteczności terapii behawioralnych.
Ze względu na wykorzystanie oprogramowania zawierającego algorytmy uczenia maszynowego urządzenia te potrafią rozpoznawać nie tylko poziom ruchu, lecz także typ aktywności – bieganie, chodzenie, sen, zabawę czy drapanie się.
Jak pomaga nam AI?
Ogromną rolę w dziedzinie petcare odgrywa także sztuczna inteligencja . Algorytmy analizy danych potrafią wykrywać subtelne zmiany w rytmie aktywności, częstotliwości odpoczynku czy wzorcach poruszania się, które dla ludzkiego obserwatora byłyby niezauważalne. W praktyce pozwala to na wczesne wykrywanie schorzeń ortopedycznych, zaburzeń neurologicznych lub stanów zapalnych, które manifestują się dopiero na poziomie mikrobehawioralnym.
Systemy AI potrafią trafnie rozpoznać m.in. wokalizacje, lizanie łap, drapanie czy chodzenie w kółko, a u kotów potrafią identyfikować subtelne zmiany w postawie ciała, częstotliwość mycia się czy sposób korzystania z kuwety. Takie rozwiązania znacząco poszerzają możliwości diagnozy behawioralnej i pozwalają specjalistom na monitorowanie efektów terapii w sposób obiektywny i ciągły.
Integracja danych z wielu źródeł otwiera nowe perspektywy w ocenie dobrostanu. Analiza informacji z obroży, czujników środowiskowych i kamer umożliwia tworzenie indywidualnych profili zachowań zwierząt, które mogą stanowić punkt odniesienia dla oceny zmian w czasie. Pozwala to na identyfikację czynników wywołujących stres lub pobudzenie, a także na dostosowanie warunków środowiskowych – takich jak natężenie hałasu, liczba bodźców czy rytm dnia – do rzeczywistych potrzeb psa lub kota. W ten sposób technologia staje się narzędziem wspierającym tworzenie środowiska przyjaznego emocjonalnie, opartego na danych, a nie wyłącznie na intuicji
Jak wspomagamy trening i pracę behawiorystów?
Urządzenia cyfrowe mają również swoje zastosowanie w treningu oraz w pracy behawioralnej. Dzięki nim możemy precyzyjnie dostosować program szkoleniowy do indywidualnych możliwości, potrzeb oraz ograniczeń danego osobnika. Dane o poziomie aktywności, rytmie snu czy reakcjach na stres pozwalają trenerowi planować intensywność sesji i czas regeneracji, minimalizując ryzyko przestymulowania lub frustracji.
Dzięki temu u psów reaktywnych można wskazać momenty, w których pobudzenie emocjonalne osiąga najwyższy poziom, a następnie tak zmodyfikować środowisko, by ograniczyć kontakt z bodźcami przekraczającymi próg tolerancji. U kotów, których stres często objawia się w sposób trudniejszy do wychwycenia, czujniki pomagają rozpoznać zmiany w rytmie aktywności lub długości odpoczynku, co stanowi cenną wskazówkę dla behawiorysty planującego interwencję.

Pies lub kot, którego potrzeby są trafnie rozpoznawane, funkcjonuje w stanie większego bezpieczeństwa emocjonalnego, co z kolei sprzyja efektywniejszej nauce i zdrowszemu funkcjonowaniu w środowisku domowym.

Zintegrowane modele opieki
Najnowsza technologia wspiera także komunikację między opiekunem zwierzęcia a specjalistą. Możliwość rejestrowania postępów, a także wspólne platformy internetowe pozwalają wszystkim specjalistom śledzić postępy w terapii, reagować na zmiany i wspólnie dostosowywać plan pracy. Integracja modelu opieki zwiększa skuteczność działań i redukuje ryzyko błędów wynikających z subiektywnej oceny. W praktyce oznacza to lepszą współpracę, bardziej spójną diagnostykę i szybsze wprowadzanie korekt, co przekłada się na realne zwiększenie dobrostanu zwierzęcia.
Jakie korzyści może mieć opiekun?
Na wykorzystaniu najnowszej technologii może skorzystać także sama relacja ze zwierzęciem. Możliwość precyzyjnego monitorowania zachowań umożliwia opiekunowi lepsze zrozumienie swojego zwierzęcia i dostosowanie interakcji do jego aktualnego stanu emocjonalnego. Redukcja stresu, wynikająca z bardziej świadomego planowania aktywności i interwencji, prowadzi do stabilizacji zachowania i poprawy relacji między człowiekiem a zwierzęciem. Pies lub kot, którego potrzeby są trafnie rozpoznawane, funkcjonuje w stanie większego bezpieczeństwa emocjonalnego, co z kolei sprzyja efektywniejszej nauce i zdrowszemu funkcjonowaniu w środowisku domowym.
Wprowadzenie nowinek technologicznych do opieki nad zwierzętami wiąże się jednak z pewnymi ograniczeniami oraz wyzwaniami. Analiza danych wymaga nie tylko zaawansowanych algorytmów, lecz także odpowiedniej interpretacji kontekstowej. Dane liczbowe, choć niezwykle użyteczne, nie mogą zastąpić wiedzy specjalisty i bezpośredniej obserwacji zachowania. Nie można w pełni zaufać technologii, gdyż niesie to ryzyko uproszczenia złożonych procesów emocjonalnych i behawioralnych, które wymagają empatii, doświadczenia i rozumienia indywidualnych różnic. Należy też pamiętać o kwestiach etycznych, takich jak ochrona danych, zapewnienie komfortu zwierzęcia podczas noszenia urządzeń czy unikanie nadmiernej inwazyjności w codziennym życiu pupila.
Celem wykorzystania technologii w życiu z psami i kotami nie powinna być idea zastąpienia człowieka, ale
wsparcie jego zdolności do rozumienia i reagowania na potrzeby zwierzęcia. Zestaw danych dostarczany przez urządzenia powinien być wykorzystywany w celu pogłębiania relacji na linii opiekun – zwierzę, a nie jako substytut realnego kontaktu.
Rynek coraz większych możliwości
Rynek zoologiczny pełen jest wszelkiego rodzaju urządzeń, które mogą usprawnić nasze życie ze zwierzętami. Na rynku dostępne są między innymi inteligentne karmniki i poidła automatyczne , które pozwalają na precyzyjne dozowanie posiłków oraz kontrolę spożycia wody z poziomu aplikacji mobilnej. Popularność zyskują także lokalizatory GPS w formie obroży lub breloków, umożliwiające śledzenie pupila w czasie rzeczywistym. W domach coraz częściej pojawiają się kamery z mikrofonem i funkcją dwustronnej komunikacji, pozwalające obserwować zwierzęta podczas nieobecności opiekuna i reagować na niepożądane zachowania. Dla aktywnych psów i kotów powstały elektroniczne zabawki interaktywne, maty węchowe sterowane aplikacją czy automatyczne wyrzutnie piłek . Również rynek zdrowia zwierząt rozwija się dynamicznie – dostępne są smart obroże monitorujące aktywność, tętno, sen i temperaturę ciała, a także urządzenia do analizy moczu czy testy genetyczne pozwalające wykryć predyspozycje chorobowe. Wszystko to sprawia, że technologia staje się narzędziem ułatwiającym opiekę oraz ważnym wsparciem w budowaniu dobrostanu i bezpieczeństwa psów oraz kotów.
W dzisiejszych czasach włączenie technologii do treningu bądź codziennego życia z pupilem staje się nie tylko trendem, lecz także konkretnym kierunkiem rozwoju. Algorytmy – często oparte na sztucznej inteligencji – stają się coraz bardziej precyzyjne w swoich działaniach. Pojawia się więc szansa na stworzenie modelu opieki, który będzie bardziej dynamiczny, empatyczny i oparty na danych. Jednak nawet najbardziej zaawansowane systemy nie są w stanie zastąpić relacji opartej na zaufaniu, empatii i wzajemnym zrozumieniu. Ostatecznie bowiem to człowiek pozostaje odpowiedzialny za interpretację sygnałów wysyłanych przez zwierzę, a technologia stanowi jedynie narzędzie, które może uczynić tę interpretację bardziej precyzyjną i skuteczną.
























































Tekst: tech. wet. Małgorzata Biegańska-Hendryk
Koty to delikatne zwierzęta, które często stają się bardzo podatne na stres. Jego przyczyny mogą być różne: zmiany środowiskowe, napięcie w grupie społecznej, problemy adaptacyjne lub podłoże zdrowotne. Niezależnie od swojego źródła stres, zwłaszcza silny i długotrwały, nie jest niczym pozytywnym. Na szczęście są metody wspomagające jego zwalczanie, po które można sięgnąć i pomóc zwierzakowi.
Wśród behawioralnych objawów stresu najczęściej stwierdza się apatię i wycofanie, drażliwość, pozakuwetową urynację lub defekację, problemy
ze snem, nasiloną wokalizację, ale też rozwój zaburzeń kompulsywnych, w tym nadmierną pielęgnację sierści aż do poziomu wyłysień i naruszeń ciągłości skóry.
Choć często problemu nie widać na pierwszy rzut oka, to wiemy, że koty potrafią bardzo źle reagować na stres. I mam tu na myśli nie tylko związane w tym zmiany w ich zachowaniu, lecz także fizjologiczne konsekwencje, do których dochodzi w organizmie, szczególnie jeśli zwierzak ma do czynienia ze stresem przewlekłym. Pod jego wpływem pogarsza się odporność, może dojść do rozwoju konkretnych jednostek chorobowych (jedną z najbardziej charakterystycznych jest idiopatyczne zapalenie pęcherza moczowego na tle stresowym, tzw. FIC), a przeciążeniu może także ulec układ nerwowy, w którym da się zaobserwować z czasem nawet postępujące zmiany degeneracyjne.
Z kolei wśród behawioralnych objawów stresu najczęściej stwierdza się apatię i wycofanie, drażliwość, pozakuwetową urynację lub defekację, problemy ze snem, nasiloną wokalizację, ale też rozwój zaburzeń kompulsywnych, w tym nadmierną pielęgnację sierści aż do poziomu wyłysień i naruszeń ciągłości skóry. Zestresowany kot gorzej się uczy i zapamiętuje, gorzej dogaduje się z innymi zwierzętami, może mieć problemy z apetytem i trawieniem oraz rozwijać kolejne rodzaje problemów, w tym np. zaburzenia lękowe.
Dlatego właśnie kociego stresu nie wolno bagatelizować, tylko należy dołożyć wszelkich starań, by w miarę możliwości usunąć go z życia zwierzaka. W tym celu trzeba wykluczyć medyczne podłoża problemu, a następnie wprowadzić terapię behawioralną, której celem jest ustalenie i wyeliminowanie przyczyny stresu lub też znalezienie rozwiązania kompromisowego. Doskonałym uzupełnieniem tego procesu mogą być dedykowane preparaty wspomagające. Trzeba jednak zaznaczyć jasno: suplementacja nie rozwiąże problemu i nie zastąpi terapii, więc nie można się nią wyręczać. Można natomiast mądrze z niej korzystać, wspierając zwierzaka (i opiekuna) w trudnych chwilach
Feromony w kocim domu
Jednym z najmniej „inwazyjnych” i najprostszych sposobów na łagodzenie stresu i napięcia jest skorzystanie z syntetycznych analogów feromonowych, które można wprowadzić do kociego otoczenia w trzech formach: dyfuzora, obroży lub spreju. W zależności od wybranej formy będą one miały różny czas działania i różny zasięg: preparat w spreju działa aktywnie przez około dwie godziny i służy do stosowania lokalnego, z kolei obroża feromonowa czy dyfuzor wpinany do kontaktu działają w sposób stały przez kilka tygodni, natomiast w przypadku tego ostatniego trzeba pamiętać o ograniczeniach,
takich jak dedykowana powierzchnia domu/ mieszkania oraz obniżenie skuteczności, np. w wyniku wietrzenia lub oddalenia się zwierzęcia od źródła preparatu. Syntetyczne analogi kocich feromonów są wykorzystywane w przekazie semiochemicznym, który zwierzęta odbierają za pośrednictwem organu nosowo-lemieszowego umieszczonego nad podniebieniem. Sygnały są charakterystyczne dla gatunku, zatem nie wpływają na inne zwierzęta w domu ani na ludzi (są bezpieczne także dla dzieci). Preparaty te podnoszą poczucie bezpieczeństwa, dają efekt wyciszenia oraz redukują napięcie. Jest to jednak bardzo łagodna forma terapii, która nie u wszystkich zwierząt przynosi oczekiwany efekt, a przy silnych bodźcach stresowych bywa zwyczajnie zbyt słaba. Dlatego należy ją łączyć z terapią behawioralną oraz nierzadko wspierać także przez inne suplementy. Uwaga! Nie należy mylić preparatów feromonowych z preparatami ziołowymi, które stanowią zupełnie inną grupę produktów i mogą dać odmienny (a czasami wręcz niekorzystny) efekt.

Suplementacja redukująca stres
Na rynku obecna jest duża ilość suplementów, których celem ma być redukcja stresu u kotów. Wiele z nich ma bardzo zbliżony skład, natomiast warto zagłębić się
Paulina Aninowska ZooDelfin
Żwirek silikonowy Delfinek – sprawdzona jakość doceniona przez właścicieli kotów.
Żwirek silikonowy Delfinek zdobył popularność wśród tysięcy miłośników kotów w całej Polsce. Dzięki bezpyłowej i hipoalergicznej formule doskonale sprawdza się u kotów wrażliwych, z alergiami lub problemami oddechowymi. To żwirek o neutralnym zapachu, delikatny dla łapek i wyjątkowo chłonny – dlatego utrzymanie świeżości i czystości kuwety jest prostsze niż kiedykolwiek. Wielu użytkowników zaznacza, że Delfinek to jeden z najwygodniejszych i najbardziej ekonomicznych żwirków silikonowych dostępnych obecnie na rynku.
Jego wytrzymała struktura pozwala na dłuższe korzystanie, co przekłada się na realne oszczędności oraz większy komfort codziennego sprzątania.
Żwirek Delfinek często jest rekomendowany przez sklepy zoologiczne i właścicieli kotów – to gwarancja jakości, bezpieczeństwa i zaufania.
Skontaktuj się z nami: kontakt@zwirekdelfinek.pl / 501 647 648
nieco w szczegóły. Na przykład część z tych preparatów jest wykonywana z udziałem hydrolizowanego białka drobiowego, co może wykluczać je ze stosowania u zwierząt wykazujących objawy nadwrażliwości układu immunologicznego na składniki pokarmowe (czyli dolegliwości zwanej potocznie „alergią pokarmową”). Z kolei niektóre substancje mają specjalne przeznaczenie, a innych należy w konkretnych przypadkach unikać.
I tak do najpopularniejszych składników suplementów redukujących stres i napięcie należą tryptofan i teanina. Tryptofan jest aminokwasem limitującym, który pełni wiele istotnych funkcji w organizmie, m.in. wspomaga układ odpornościowy, zmniejsza nadciśnienie, obniża stany lękowe i działa uspokajająco jako inhibitor zwrotnego wychwytu serotoniny. W organizmie kota jest niezbędny do prawidłowej syntezy melatoniny, która odpowiada za rytm snu i czuwania. W naturalnych warunkach kot dostarcza go sobie z mięsa swych ofiar, natomiast w suplementach jest umieszczany w postaci l-tryptofanu.
Z kolei pozyskiwana z liści zielonej herbaty teanina działa uspokajająco i relaksująco, wspiera koncentrację, poprawia jakość snu i pomaga łagodzić stres, wpływając na poziom neuroprzekaźników, takich jak GABA, dopamina i serotonina. Ponadto zmniejsza aktywność fal mózgowych o wysokiej częstotliwości, jednocześnie podnosząc aktywność fal alfa, co prowadzi do stanu relaksu umysłu, ale bez efektu senności. W suplementacji korzysta się z niej w postaci l-teaniny.
Kolejnym ważnym elementem redukującym stres i napięcie jest kompleks witamin z grupy B. Ich główną funkcją jest w tym wypadku odżywianie i regeneracja układu nerwowego, co korzystnie wpływa na ogólne samopoczucie zwierzaka. Jeśli chodzi o stymulujące oddziaływanie na układ nerwowy, to wykazuje je też obecna w części suplementów lecytyna , która jest kluczowym budulcem mózgu i otoczki mielinowej w komórkach nerwowych. Z kolei powiązana z nią ściśle cholina bierze udział w przekazywaniu impulsów nerwowych. To połączone działanie poprawia zdolność zapamiętywania i koncentrację, ale także pomaga łagodzić objawy depresji i pozytywnie wpływa na nastrój.

Innym składnikiem często wykorzystywanym w suplementach doustnych, ale też w różnego rodzaju preparatach wziewnych, jest kozłek lekarski oraz wyciąg z niego – bardziej popularną nazwą tego zioła jest waleriana . Działa pobudzająco i ożywczo, pomaga przezwyciężyć lęk, jednak u kotów z tendencją do zachowań agresywnych może nasilać reakcje konfrontacyjne, aż do poziomu wywoływania ataków na ludzi lub inne zwierzęta. Dlatego też trzeba być bardzo ostrożnym, sięgając po jakiekolwiek preparaty z tym składnikiem, i dobierać je świadomie do konkretnego przypadku.
Z kolei substancją dedykowaną kotom z problemami lękowymi jest alfa-kazozepina – peptyd oryginalnie wyselekcjonowany z pokarmu kotki, który kocięta spożywają w pierwszym okresie życia. Działa poprzez regulację układu nerwowego i wspiera naturalne mechanizmy wyciszające w organizmie, nie powodując przy tym senności ani uzależnienia. Alfa-kazozepina pomaga w łagodzeniu stresu, niepokoju i lęku, poprawiając samopoczucie także u zwierząt dorosłych.
O wiele rzadziej natomiast spotyka się w suplementach ekstrakt z hibiskusa syryjskiego (Hibiscus syriacus) standaryzowany na zawartość gossypiny. Substancja ta (3,5,7,3,4- pentahydroksy-8-0-glukozylo-glukozyd) jest ligandem dla receptorów kwasu γ-aminomasłowego typu A (GABAA), dzięki czemu stanowi wsparcie dla organizmu w sytuacjach stresowych. Dodatkowo wykazuje również działanie antyoksydacyjne oraz przeciwzapalne, co także jest korzystne, zwłaszcza w przypadku postresowego obniżenia odporności.
UWAGA! Wszystkie powyższe składniki suplementacyjne powinny być stosowane zgodnie z instrukcją producenta oraz w porozumieniu z prowadzącym lekarzem weterynarii i/lub behawiorystą. Ponieważ większość z nich to substancje naturalne, ich okres wysycenia w organizmie jest dłuższy niż w przypadku leków, dlatego zazwyczaj podstawowy czas przeznaczony na kurację wynosi od 2 do 4 tygodni, w zależności od konkretnego przypadku. Wiele z nich można podawać dłużej, jednak wymaga to indywidualnego dopasowania.
Waleriana
u kotów z tendencją do
zachowań
agresywnych
może nasilać reakcje konfrontacyjne, aż do poziomu wywoływania ataków na ludzi lub inne zwierzęta.
Wsparcie farmakologiczne
Zdarza się, że suplementy to za mało. Szczególnie dotyczy to przypadków, gdy zwierzę z powodu stresu lub lęku nie jest w stanie normalnie funkcjonować lub gdy dochodzi na tym tle do agresji (z autoagresją i okaleczaniem włącznie). W takim przypadku należy bezzwłocznie skonsultować się z lekarzem weterynarii zajmującym się farmakoterapią behawioralną, który pomoże dobrać odpowiednie leki, dostosuje dawki oraz rozpisze czas trwania kuracji. Nie można bowiem pozostawiać kota w stanie silnego stresu lub leku bez pomocy, gdyż z dużym prawdopodobieństwem pociągnie to za sobą dalsze, coraz gorsze skutki.
Postępowanie w okresie świąt i sylwestra
Dla wielu kotów okres świąteczno-sylwestrowy to szczególnie stresujący czas w ciągu roku. Dlatego warto z wyprzedzeniem pomyśleć o działaniach zaradczych, takich jak zakup feromonów do kontaktu, ewentualnie wprowadzenie już na kilka dni przed świętami łagodnych suplementów poprawiających samopoczucie. U zwierząt szczególnie wrażliwych warto kontynuować te działania
przez cały okres świąteczny aż do pierwszych dni stycznia – szczególnie, jeśli zwierzęta źle znoszą huk petard i obecność gości w domu. Oczywiście dobór konkretnego środka trzeba skonsultować ze specjalistą.
Poza działaniami o charakterze suplementacyjnym warto także zadbać o wsparcie behawioralne, takie jak bezpieczne kryjówki i miejsca odosobnienia, uczulenie osób odwiedzających dom, aby nie naprzykrzały się kotu (szczególnie dotyczy to dzieci), ograniczenie liczby bodźców zewnętrznych (np. przez zamknięcie i zasłonięcie okien) oraz zadbanie o ogólne bezpieczeństwo zwierząt, szczególnie w sylwestrową noc.
Choć środki redukujące stres i napięcie u zwierząt są bardzo przydatne, to jednak trzeba pamiętać, że skuteczne rozwiązanie problemu następuje dopiero wtedy, gdy stresor zostanie realnie usunięty z kociego świata. Jeśli bowiem napięcie psychiczne jest bardzo silne, to żadne suplementy go nie przezwyciężą, a skazywanie zwierzęcia na funkcjonowanie w stanie ciągłego dyskomfortu jest odwrotnością dbałości o jego dobrostan.










Innowacyjne narzędzie w walce z kleszczami

Tekst: Joanna Zarzyńska
Kleszcze są groźnymi wektorami przenoszącymi liczne choroby, zarówno u ludzi, jak i zwierząt domowych. W Polsce rośnie zachorowalność na boreliozę i kleszczowe zapalenie mózgu (KZM) – w 2023 roku odnotowano 25 244 przypadki boreliozy i 659 przypadków KZM. Zmiany klimatyczne spowodowały, że kleszcze są aktywne coraz dłużej – łagodne zimy pozwalają im na żer prawie przez cały rok. To powoduje, że opiekunowie psów i kotów, również tych aktywnych jedynie w przestrzeni miejskiej, bardzo niepokoją się zagrożeniem zdrowia swoich pupili, którym zagraża wiele chorób odkleszczowych. Do najczęstszych należą babeszjoza, anaplazmoza, erlichioza, hepatozoonoza oraz hemotropowa mykoplazmoza. Należy pamiętać, że pojedynczy kleszcz może przenosić więcej niż jednego patogena.
W ostatnich latach dużą uwagę zwrócono na wykorzystanie naturalnych wrogów kleszczy – grzybów entomopatogennych (owadobójczych). Są to mikroorganizmy szeroko występujące w przyrodzie, potrafiące infekować i zabijać pajęczaki. Wśród nich klasycznymi przykładami są Metarhizium
anisopliae oraz Beauveria bassiana – gatunki szczegółowo przebadane jako biopestycydy.
Tradycyjne metody zwalczania kleszczy i profilaktyka
Na całym świecie rozpoznano około 900 gatunków kleszczy, w Europie zagraża nam aż 77 gatunków. W Polsce najbardziej obawiamy się kleszczy twardych z rodziny Ixodidae. Obecnie podstawą ochrony pupili przed kleszczami są chemiczne środki owadobójcze –stosujemy je w formie tabletki, kropli spot-on czy obroży z substancjami bójczymi i repelentnymi. Kiedyś mówiono o sezonowej, wiosennej i jesiennej ochronie przed kleszczami, dzisiaj komunikuje się opiekunom konieczność stosowania zabezpieczeń przez cały rok. Rekomenduje się także regularne przeglądanie psów po spacerach. Wiele osób obawia się skutków długotrwałego stosowania substancji chemicznych zarówno na zdrowie zwierząt, jak i na środowisko. Ponadto syntetyczne akarycydy mogą prowadzić do wzrostu odporności kleszczy na środki chemiczne. Opiekunowie szukają alternatyw w postaci naturalnych substancji repelentnych (jak czystek) czy np. zawieszek z ultradźwiękami. Preparaty chemiczne pozostają złotym standardem zwalczania kleszczy, ale rośnie zainteresowanie alternatywami opartymi na środkach biologicznych.
Grzyby entomopatogenne – natura w służbie zwalczania kleszczy
W ostatnich latach dużą uwagę zwrócono na wykorzystanie naturalnych wrogów kleszczy – grzybów entomopatogennych (owadobójczych). Są to mikroorganizmy szeroko występujące w przyrodzie, potrafiące infekować i zabijać pajęczaki. Wśród nich klasycznymi przykładami są Metarhizium anisopliae oraz Beauveria bassiana – gatunki szczegółowo przebadane jako biopestycydy. Grzyby te zabijają kleszcze na różnych etapach rozwoju (jaja, larwy, nimfy, postaci dorosłe). W badaniach laboratoryjnych wykazywano, że aplikacja konidiów (zarodników) Metarhizium czy Beauveria powoduje bardzo wysoką śmiertelność kleszczy – nawet do 99% w przypadku odpowiednich szczepów przeciw larwom kleszczy Dermacentor albipictus. Dodatkowo pewne gatunki (np. Purpureocillium lilacinum, dawniej Paecilomyces lilacinus) infekują jaja kleszczy, hamując wylęg larw, co oznacza skuteczną prewencję rozwoju populacji pasożytów. Grzyby entomopatogenne cechuje wysoka specyficzność – atakują głównie określone grupy owadów czy pajęczaków – podkreśla się margines bezpieczeństwa dla ludzi oraz zwierząt. W przeciwieństwie do chemii nie ku -


mulują się w organizmach wyższych i są biodegradowalne. W pracach naukowych wskazuje się je jako przyszłościowe bezpieczne i ekologiczne rozwiązanie dla kontroli kleszczy. Przy pracach wdrożeniowych jednak konieczna jest ocena wpływu na organizmy niecelowe (np. owady pożyteczne, jak zapylacze).
Mechanizm działania grzybów entomopatogennych
Grzyby entomopatogenne (ang. EPF entomopathogenic fungi) działają w kilku etapach, powodując zakaźne mykozy u kleszczy. Na przykład M. anisopliae czy B. bassiana rozmnażają się przez konidia (zarodniki przetrwalnikowe), które są lekkie i mogą unosić się w powietrzu. Konidia te opadają na kutikulę kleszcza dzięki właściwościom hydrofobowym powierzchni ciała pajęczaków. Po przylgnięciu zarodnik kiełkuje i rozwija kiełek grzybni, którą wnika w miękkie tkanki kleszcza za pomocą enzymów hydrolitycznych (głównie proteaz, lipaz i chitynaz).
Enzymy lipolityczne zaburzają też równowagę lipidową kleszczy. Wnikając do wnętrza ciała kleszcza, grzyb rozrasta się wewnątrz, korzystając z jego składników odżywczych. W czasie rozwoju grzyb produkuje liczne toksyczne metabolity (np. beauwericyna, bassiannolid, destruksyny). Te związki hamują procesy fizjologiczne kleszcza – uszkadzają tkanki i prowadzą do paraliżu. Cały proces od zakażenia do śmierci trwa zazwyczaj kilka dni – co daje efekt utrzymujący się dłużej niż działanie wielu środków chemicznych, gdyż wymaga czasu na rozwój grzyba. Po śmierci kleszcza grzyb może sporulować
– czyli produkować kolejne konidia – co może prowadzić do zarażenia kolejnych osobników.
W badaniach z lasów zasiedlonych przez kleszcza Ixodes ricinus udało się wyizolować 53 szczepy grzybów entomopatogennych należących do rodzajów Metarhizium, Beauveria i Isaria. Testy laboratoryjne wykazały, że niektóre szczepy mają wysoką skuteczność wobec dorosłych osobników i nimf I . ricinus. Najsilniejszy efekt miała odmiana Metarhizium anisopliae pochodząca z gleby tego środowiska.
Prowadzono też badania nad grzybami zwalczającymi kleszcza psiego (Rhipicephalus sanguineus) i wykazano, że szczepy endemiczne Beauveria bassiana działają na wszystkie stadia rozwojowe tego kleszcza.
Przykładowe formy preparatów
Aktywne formy preparatów biobójczych oparte na tych grzybach to przede wszystkim suszone zarodniki (konidia) w postaci proszku, granulatu lub zawiesiny. Konidia stanowią aktywną substancję czynną – po aplikacji do środowiska (np. poprzez oprysk terenu) łatwo przylegają do oskórka kleszczy i rozpoczynają infekcję. Produkty biologiczne mogą przybierać różne formy: granulaty do wysiewu na trawnik czy ściółkę leśną, proszki do sporządzania oprysków (zwłaszcza wokół bud dla psów, wybiegów, ogrodzeń), a nawet tzw. zawiesiny do oprysku roślin i gleby. Podkreśla się, że aktywna forma to zawsze konkretny szczep grzyba. Nie każdy szczep grzyba jest równie skuteczny wobec każdego gatunku kleszcza czy stadium rozwojowego – dobór szczepu ma kluczowe znaczenie.
sklepów
i ich klientów grzyby te są dodatkowym
narzędziem: preparat biologiczny może być polecany jako uzupełnienie
profilaktyki (obok obroży, kropli, badań weterynaryjnych) zwłaszcza
tam, gdzie oczekiwane jest minimum chemii.
Wilgotna ściółka i zacienione miejsca sprzyjają rozwojowi grzybni, więc warto aplikować substancje po deszczu lub wczesnym rankiem. Ponieważ niektóre grzyby są wrażliwe na UV, najlepiej działać wieczorem lub w pochmurny dzień. Wysoka temperatura, promieniowanie UV (UV-A i UV-B) oraz niski poziom wilgotności mogą znacząco obniżać przeżywalność konidiów oraz efektywność infekcji. Prace nad formulacjami (np. mieszaniny olejowe, mikroenkapsulacja) mogą poprawić trwałość konidiów w warunkach środowiskowych i zwiększyć skuteczność.
Preparaty biobójcze z konidiami nie zastępują konsultacji z lekarzem weterynarii czy profilaktyki wewnętrznej (np. stosowania repelentów na zwierzęta), ale mogą stanowić uzupełnienie zintegrowanej kontroli inwazji kleszczy (ang. Integrated Tick Management, ITM). W wielu krajach zastosowanie takich biopreparatów wymaga rejestracji jako biopestycyd, co może być barierą. Przed masowym stosowaniem konieczne są długofalowe badania terenowe, które ocenią skutki stosowania EPF na populacje kleszczy, ale też na ekosystem, w tym wpływ na inne bezkręgowce.
Dla właścicieli sklepów zoologicznych i ich klientów grzyby te są dodatkowym narzędziem: preparat biologiczny może być polecany jako uzupełnienie profilaktyki (obok obroży, kropli, badań weterynaryjnych) zwłaszcza tam, gdzie oczekiwane jest minimum chemii (np. w otoczeniu dzieci czy małych zwierząt). Należy zaznaczyć, że stosowanie grzybów entomopatogennych wymaga cierpliwości – efekt pojawia się po kilku dniach, ale jest długotrwały. W ujęciu praktycznym pozwalają wprowadzić ekologiczne uzupełnienie do arsenału środków przeciwkleszczowych, co jest cenne w perspektywie zrównoważonej profilaktyki zdrowia zwierząt domowych.
Wybrane pozycje literatury:
• Barbieri A. i wsp., Field efficacy of Metarhizium anisopliae oil formulations for control of cattle tick Rhipicephalus microplus, PubMed (2023).
• Dyczko D. i wsp., Entomopathogenic Fungi in Forest Habitats of Ixodes ricinus, Insects, 2024.
• Kalayou S. i wsp., A randomized controlled trial of Tickoff® (Metarhizium anisopliae) – field trial, 2024.
• Rajput M. i wsp., E ntomopathogenic Fungi as Alternatives to Chemical Acaricides: Challenges, Opportunities and Prospects for Sustainable Tick Control, Insects, 2024.

Tekst: Ada Włoch
Master of Parrot Diseaster certyfikowana behawiorystka papug
Papugi to jedne z najbardziej wyspecjalizowanych ptaków pod względem anatomicznym. Ich dzioby i stopy nie są tylko narzędziami do spożywania pokarmu, lecz także stanowią wielofunkcyjny zestaw „narzędzi”, który umożliwia eksplorację, wspinaczkę, manipulację przedmiotami czy rozwiązywanie łamigłówek. Co ciekawe, u wielu gatunków można zaobserwować wyraźną lateralizację, czyli lewo- lub prawonożność, podobną do ludzkiej prawo- i leworęczności. Dbanie o zdrowie dzioba i papuzich stóp ma kluczowe znaczenie dla komfortu życia oraz rozwoju behawioralnego i emocjonalnego papugi.
stopy mają wyjątkową
Papuzie stopy mają wyjątkową budowę, określaną jako zygodaktylia . Oznacza to, że dwa palce są skierowane ku przodowi (palce II i III), a dwa pozostałe ku tyłowi (palce I i IV). Dzięki takiemu ustawieniu palców ptaki mogą chwytać gałęzie, stabilnie się na nich utrzymywać, a także manipulować przedmiotami niemal tak sprawnie, jakby miały przeciwstawny kciuk. Na spodniej stronie stóp znajdują się poduszki skórne, tzw. podoteka, które odgrywają rolę amortyzatorów i chronią stawy przed nadmiernym przeciążeniem. Podoteka pomaga rozkładać nacisk równomiernie – dlatego tak ważne są odpowiednie żerdzie dla papug, które nie spowodują odcisków i uszkodzenia podoteki.
Właściwy dobór żerdzi
Gładkie toczone żerdzie czy plastikowe patyki mogą powodować bolesne odciski i uszkodzenia stóp. Papugi korzystają ze swoich stóp podczas całego swojego życia –stojąc, jedząc, śpiąc, wspinając się czy czyszcząc, dlatego konieczne jest przygotowanie różnorodnych rozmiarów, średnic i faktur żerdzi, by jak najbardziej odwzorować naturalne środowisko i różnorodne powierzchnie. Ze


Fot. 1. Papugi są zwinne i sprawne właśnie dzięki niezwykłej budowie stóp, która jest określana zygodaktylią.
swoich niezwykłych zdolności korzystania ze stóp słyną kakadu, które w stopach trzymają nawet proste narzędzia służące do pozyskania pokarmu. Białobrzuszki zaś to mistrzynie skoków i akrobacji, które możliwe są dzięki ich silnym stopom. Papugi grzebiące, takie jak modrolotki, mają zaś skoki bardzo długie, smukłe, a palce zwinne i cienkie.


2., 3., 4. Papugi powinny korzystać z żerdzi o nierównomiernej powierzchni, jak naturalne żerdzie z korą brzozy czy wierzby, gałęzie korkowe, naturalne liany.



Fot. 5., 6., 7. Białobrzuszki mają nogi krótkie, silne i krępe w porównaniu z modrolotkami i ich długimi i smukłymi skokami. Kakadu zaś mają niezwykle silne i zwinne stopy, które umożliwiają im manipulację na wysokim poziomie.
papug składa się z górnej szczęki (maxilla), dolnej szczęki (mandibula), rogowej okrywy (ramphotheca) oraz języka.
Równie fascynująca jak budowa stóp jest anatomia dzioba papug. Składa się on z górnej szczęki (maxilla), dolnej szczęki (mandibula), rogowej okrywy (ramphotheca) oraz języka. Górna szczęka jest ruchoma, co wyróżnia papugi na tle większości ptaków. Dolna szczęka, dzięki silnym mięśniom, potrafi wytworzyć ogromny nacisk rozłupujący twarde orzechy. Duże gatunki ar i kakadu są w stanie złamać człowiekowi palec, uszkodzić nerwy czy spowodować poważne rany uszu czy okolic twarzy! Rogowa okrywa dzioba rośnie przez całe życie, dlatego musi być regularnie ścierana podczas życia ptaka. Język, silny, mięsisty i bogaty w receptory dotykowe, odgrywa ważną rolę w precyzyjnym manipulowaniu pokarmem. Dzięki ruchomej górnej szczęce i sprężystej strukturze dzioba papugi mogą wykonywać skomplikowane ruchy: szczypać, łamać, miażdżyć, ale też manipulować przedmiotami w sposób niezwykle finezyjny. W praktyce dziób i nogi tworzą u nich system podobny do dwuręcznej pracy, pozwalający na jednoczesne przytrzymywanie i obrabianie pożywienia.
Dzioby i stopy papug mają wiele funkcji, nie służą tylko do zdobywania pożywienia. Oczywiście najważniejsza z nich to zdobywanie i rozdrabnianie pokarmu, jednak potrafią one dużo więcej. Dziób i stopy służą papugom także do wspinaczki, często można zauważyć, jak ptak


8. Dziób kakadu palmowej czy ary hiacyntowej robi wrażenie, a służy on do otwierania niezwykle twardych orzechów palmowych.
używa dzioba jako dodatkowego punktu podparcia, niemal jak haka alpinistycznego. Co więcej, papugi wykorzystują dziób i stopy również do komunikacji i obrony. Mowa ciała zakłada np. specyficzne uderzenia czy ruchy dziobem, chwytanie przeciwnika nogą, odpychanie. Nie wolno też zapominać o higienie: czyszczenie piór i ciała jest podstawą utrzymania zdrowego upierzenia.

Fot. 9. Dziób i stopy służą również do komunikacji. Fot. 10. Zwinne, sprawne i niezwykle zdolne – tak można określić zdolności wspinaczkowe papug.
Zabawki, łamigłówki, puzzle umożliwiają użycie nóg i dzioba w sposób przypominający zachowania w naturze, a trening behawioralny nie tylko angażuje kończyny, lecz także wzmacnia więź z opiekunem.
Jak zadbać o łapy i dziób?
Dbanie o zdrowie dzioba i stóp to jeden z kluczowych obowiązków opiekuna papug. Naturalne ścieranie dzioba zapewniają gałęzie drzew, kawałki kory dębu korkowego czy konary o różnej twardości. Zapewnienie żerdzi o zróżnicowanej średnicy, fakturze i materiale (naturalne gałęzie, liny, korek) pozwala zapobiegać powstawaniu odcisków, uszkodzeń i zwyrodnień. Utrzymaniu zdrowia sprzyjają także ćwiczenia i wzbogacenia środowiska. Żerowanie i zabawa pozwalają papudze rozwijać naturalne zachowania związane ze zdobywaniem pożywienia i aktywizuje jej umysł. Zabawki, łamigłówki, puzzle umożliwiają użycie nóg i dzioba w sposób przypominający zachowania w naturze, a trening behawioralny, taki jak targetowanie czy uczenie „podawania łapki”, nie tylko angażuje kończyny, lecz także wzmacnia więź z opiekunem. Odpowiednia dieta jest tu równie ważna – wapń i minerały wspierają zdrowe kości i dzioby, a warzywa bogate w witaminę A, takie jak marchew, dynia czy papryka, odpowiadają za prawidłowy stan rogowej okrywy dzioba i zdrowy naskórek.
Dbanie o zdrowie dzioba i papuzich stóp ma kluczowe znaczenie nie tylko dla komfortu życia, ale też dla rozwoju behawioralnego i emocjonalnego papugi.

Fot. 11. Czyszczenie piór wymaga precyzji i sprawnego dzioba.


Jak wygląda handel rybami akwariowymi na wietnamskiej wyspie?

Tekst: mgr inż. Paweł Wróblewski
Katedra Genetyki i Ochrony Zwierząt, Instytut Nauk o Zwierzętach, Szkoła Główna Gospodarstwa Wiejskiego w Warszawie
Phu Quoc, największa wyspa Wietnamu, położona w Zatoce Tajlandzkiej, od lat przyciąga turystów swoimi białymi plażami, turkusową wodą i niezwykłym bogactwem przyrody. To miejsce, gdzie tropikalne lasy spotykają się z malowniczymi wioskami rybackimi, a życie toczy się w rytmie oceanu. Choć większość odwiedzających kojarzy wyspę z odpoczynkiem i świeżymi owocami morza, niewielu zdaje sobie sprawę, że Phu Quoc skrywa również barwny, choć mniej znany handel rybami akwariowymi.
Na wyspie Phu Quoc działają hodowle gupików, a ich nadmiar bywa wypuszczany do lokalnych wód, co prowadzi do pojawienia się tych ryb w naturalnym środowisku. W handlu dostępne są ponadto różne gatunki brzan, pielęgnic i pielęgniczek, które trafiają zarówno do akwariów domowych, jak i hotelowych akwariów dekoracyjnych.
Mimo że Phu Quoc nie jest dużą wyspą, lokalny handel akwarystyczny kwitnie tu zaskakująco intensywnie. Wzdłuż głównych ulic i w mniejszych miasteczkach można znaleźć liczne punkty handlowe wypełnione akwariami i szklanymi zbiornikami mieniącymi się feerią barw. Z przeprowadzonych obserwacji wynika, że na wyspie działa około dwudziestu sklepów specjalizujących się w sprzedaży ryb akwariowych. To imponująca liczba, biorąc pod uwagę rozmiar wyspy i jej przede wszystkim turystyczny charakter. Handel ten przyciąga zarówno lokalnych pasjonatów, jak i odwiedzających z kontynentu. Dla wielu mieszkańców stał się on ważnym źródłem dochodu, zwłaszcza że ryby i akcesoria są tu znacznie tańsze niż w dużych miastach. W niektórych miejscach obok tradycyjnych sklepów funkcjonują również małe hodowle, które dostarczają ryby na rynek lokalny, a także do eksportu na inne części Wietnamu.
W ofercie sklepów akwarystycznych na Phu Quoc można znaleźć szeroki wybór gatunków. Największym zainteresowaniem cieszą się ryby genetycznie modyfikowane (GMO), takie jak fluo brzanki sumatrzańskie czy fluo tetry. Te ryby, choć w Polsce objęte zakazem sprzedaży, na Phu Quoc są prawdziwym hitem i często stanowią główny element wystroju domowych akwariów. Nie brakuje też gupików w różnych odmianach barwnych oraz popularnych bojowników. Co ciekawe, na wyspie działają również hodowle gupików, a ich nadmiar bywa wypuszczany do lokalnych wód, co prowadzi do pojawienia się tych ryb w naturalnym środowisku. W handlu dostępne są ponadto różne gatunki brzan, pielęgnic i pielęgniczek, które trafiają zarówno do akwariów domowych, jak i hotelowych akwariów dekoracyjnych. Oprócz samych ryb w sklepach można kupić pełne wyposażenie akwarystyczne – od filtrów i pomp, przez oświetlenie LED, po dekoracje i po -


Ryby GMO oferowane są w każdym sklepie.
karmy importowane z Chin lub Tajlandii. W sklepach na Phu Quoc nie znajdziemy sprzętu topowych europejskich marek. Powód jest bardzo prosty. Bardziej opłacalne jest pozyskiwanie sprzętu z Chin, które są bliżej, niż z Europy. Nie ukrywajmy, sprzęt z Chin niestety odbiega jakością od sprzętu z Europy. Pod względem wykonania sprzęt z Europy jest zdecydowanie lepszy. Azjatyckie rozwiązania są prostsze, ale też wadliwe po krótkim użytkowaniu. Przykładem może być napowietrzacz zdalny na baterie. Można go używać bez dostępu do prądu. Konstrukcja jest niezwykle prosta, jednak po zalaniu jest już niezdatny do użytku.
Ceny w sklepach
Ceny ryb akwariowych na Phu Quoc potrafią zaskoczyć każdego miłośnika akwarystyki z Europy. Za jednego osobnika ryby genetycznie modyfikowanej, takiej jak fluo brzanka sumatrzańska czy fluo tetra, zapłacić można zaledwie 1–2 złote. Dla porównania w Polsce te same gatunki – gdyby były dopuszczone do sprzedaży – kosztowałyby kilkakrotnie więcej, często nawet powyżej 10 zł za sztukę. Pielęgnice wyceniane są tu na około 4 zł za rybę, natomiast większe brzany, mierzące około 10 centymetrów, kosztują w granicach 10 zł za osobnika. W polskich sklepach zoologicznych te same gatunki osiągają ceny od 20 do 60 zł, a niektóre bardziej okazałe odmiany nawet więcej.
Nie tylko ryby są tu wyjątkowo tanie. Równie przystępne okazują się ceny akwariów i akcesoriów. Za szklany zbiornik o pojemności 10 litrów sprzedawcy żądają średnio 15 zł, a większy 60-litrowy można kupić już za
około 40 zł. W Polsce podobne zbiorniki kosztują odpowiednio 70–100 zł i 200–300 zł, co pokazuje, jak ogromna jest różnica w kosztach. Sprzęt akwarystyczny również kusi cenami – napowietrzacz z zasilaniem bateryjnym można dostać za około 8 zł, podczas gdy w Polsce za taki sam produkt trzeba zapłacić co najmniej 50–70 zł. Większość akcesoriów jest sprowadzana z Chin lub Tajlandii, co tłumaczy ich niską cenę, ale też sprawia, że rynek ten jest niezwykle konkurencyjny.
Dobrostan sprzedawanych ryb
Kwestia dobrostanu ryb akwariowych na Phu Quoc niestety pozostawia wiele do życzenia. Wietnamczycy podchodzą do hodowli ryb ozdobnych przede wszystkim od strony estetycznej – liczy się efekt wizualny, a nie warunki życia zwierząt. Często są to małe, ciasne zbiorniki, w których pływa zbyt wiele ryb na zbyt małej przestrzeni. Najważniejsze jest, aby akwarium zawierało wiele ozdób, plastikowych roślin i kamyków. Takie zbiorniki często są ustawiane w miejscach o dużym natężeniu ruchu – na przykład na blatach recepcji hoteli, w restauracjach, kawiarniach, gdzie ryby przez cały dzień są narażone na hałas, wibracje i ciągłe ruchy ludzi wokół. W takich warunkach trudno mówić o spokoju czy właściwym dobrostanie. Azjatyckie podejście do akwakultury wciąż różni się od tego znanego w Europie. W Wietnamie ryby są raczej postrzegane jako element wystroju lub symbol szczęścia niż istoty wymagające szczególnej troski. Podobną sytuację można zaobserwować w lokalnych sklepach akwarystycznych. Ryby przebywają tam
W Wietnamie ryby są raczej postrzegane jako element wystroju lub symbol szczęścia niż istoty wymagające szczególnej troski. Podobną sytuację można zaobserwować w lokalnych sklepach akwarystycznych. Ryby przebywają tam w zwykłej wodzie kranowej, bez dodatku uzdatniaczy, a wiele zbiorników jest pozbawionych podstawowej filtracji.
w zwykłej wodzie kranowej, bez dodatku uzdatniaczy, a wiele zbiorników jest pozbawionych podstawowej filtracji. Niektóre z ryb wystawionych na sprzedaż wykazują objawy osłabienia lub infekcji, jednak dla sprzedawców liczą się przede wszystkim kolor i żywotność w momencie zakupu. W takich realiach dobrostan ryb schodzi na dalszy plan, a nadrzędnym celem staje się przyciągnięcie wzroku klienta.
Handel rybami akwariowymi na Phu Quoc to zjawisko pełne kontrastów, z jednej strony zachwyca różnorodnością gatunków, barw i niskimi cenami, z drugiej jednak ujawnia problemy związane z brakiem troski o dobrostan zwierząt i jakość oferowanego sprzętu. Kolorowe akwaria wypełnione rybami GMO stały się symbolem estetyki, lecz często powstają kosztem dobrostanu ryb. Choć handel ten przynosi mieszkańcom dochody i wpisuje się w kulturę wyspy, ukazuje też, jak odmiennie w Azji jest postrzegane znaczenie opieki nad zwierzętami. Phu Quoc urzeka barwami i bogactwem
życia, ale za tym kolorowym światem kryje się mniej widoczna prawda, że piękno akwariów często nie idzie w parze z troską o ich mieszkańców. Phu Quoc pokazuje, jak dynamicznie może rozwijać się rynek akwarystyczny w Azji. Być może w przyszłości, wraz ze wzrostem edukacji z zakresu akwakultury, także tu pojawi się większa troska o dobrostan ryb.

Akwarium postawione w hotelowej recepcji bogate w ryby GMO.

sprzedawane w jednym ze sklepów na wietnamskiej wyspie.
Do oferty BIOFEED ZOO dołączyła mokra karma Tasty Dogs Life w poręcznych, 150-gramowych saszetkach. To idealna porcja dla małych psiaków oraz klientów, którzy preferują wygodne, mniejsze opakowania. Saszetki Tasty Dogs Life to pełnoporcjowe dania w galaretce, stworzone z myślą o zdrowiu, prawidłowym rozwoju i doskonałym samopoczuciu psów.
W saszetkach zamknięto pyszne, mięsne formuły, które łączą wysoką smakowitość z funkcjonalnymi składnikami wspierającymi organizm psa. Wszystkie receptury oparte są na 90% mięsa i produktów pochodzenia zwierzęcego, co stanowi naturalne wsparcie dla mocnych mięśni i energii.
Karma jest bezzbożowa, dzięki czemu świetnie sprawdza się u psów o wrażliwym układzie pokarmowym. Prebiotyki wspierają mikroflorę jelit i odporność, a zestaw witamin i minerałów pomaga utrzymać dobrą kondycję każdego dnia. Dodatkowo każdą recepturę wzbogacono o olej z łososia (kwasy tłuszczowe omega-3 i omega-6) oraz naturalne dodatki – m.in. jajko, marchew, jabłko, dynię, żurawinę czy pomidory, które wspierają trawienie, odporność i ogólną kondycję pupila.
W sprzedaży aż 6 smakowych wariantów, tak aby łatwiej dopasować produkt do potrzeb każdego pupila.
Dla szczeniąt (JUNIOR)
• Tasty Dogs Life Junior – Danie z cielęciną w galaretce
• Tasty Dogs Life Junior – Danie z kaczką w galaretce
Dla dorosłych psów (ADULT)
• Tasty Dogs Life – Danie z cielęciną w galaretce
• Tasty Dogs Life – Danie z kaczką w galaretce
• Tasty Dogs Life – Danie z indykiem w galaretce
• Tasty Dogs Life – Danie z jeleniem w galaretce

Pyszne nowości dla kotów
Styl

i Wygoda dla Twojego Pupila! Poznaj nowości od marki PLATINI!
Marka PLATINI od lat wyznacza kierunek w świecie psiej mody, łącząc elegancję z najwyższą jakością wykonania. Nasze ubranka to nie tylko stylowy dodatek, lecz przede wszystkim gwarancja komfortu, ciepła i swobody dla każdego czworonoga. Uszyte z miękkich, przewiewnych i elastycznych tkanin, doskonale dopasowują się do psiego ciała, nie krępując ruchów podczas spacerów i zabawy.
PLATINI to jedna z najbardziej uznanych marek odzieży dla psów w Polsce, ceniona zarówno przez opiekunów zwierząt, jak i sklepy zoologiczne, które od lat darzą nas zaufaniem i regularnie zamawiają nasze produkty. Obecnie rozszerzamy ofertę o nowe modele – jeszcze bardziej funkcjonalne, modne i dopracowane w każdym szczególe.
Z PLATINI Twój pupil zawsze prezentuje się stylowo! Skontaktuj się z nami, by poznać szczegóły oferty i odkryć najnowsze propozycje marki PLATINI !
Skontaktuj się z nami już dziś: kontakt@platini.pl / 501-647-648
Nekko Daily to pełnoporcjowe karmy mokre dla kotów i kociąt, które idealnie sprawdzą się jako codzienny posiłek. Nie zawierają zbóż, więc świetnie sprawdzą się w diecie kotów z tendencją do alergii pokarmowej. Smakowita receptura w formie soczystych kawałków w sosie zadowoli nawet najbardziej wybredne koty, a wysoka wilgotność karmy zapewni wsparcie w utrzymaniu odpowiedniego poziomu nawodnienia organizmu. Wzbogacona tauryną – ważnym aminokwasem w diecie na zdrowe serce i odporność.
Saszetki 85g dostępne w 5 smakach:
• Kitten z jagnięciną w sosie
• Adult z wątróbką z kurczaka w sosie
• Adult z królikiem w sosie
• Adult Sterilised z indykiem w sosie
• Adult Hairball kurczak w sosie
Nekko Daily to propozycja dla opiekunów, którzy szukają smacznych i przystępnych cenowo posiłków na co dzień dla swoich mruczków.
www.nekko.pl





Dystrybutor: Rokus Piotr Jędrzejczak, www.rokus.pl, dzialhandlowy@rokus.pl, tel. +48 523 593 180
Wiemy, że mały kawałek natury tuż za domem potrafi wnieść wiele radości. Odpowiedzialnie dokarmiając jeże, pomagamy im zachować siły i dobre samopoczucie przez cały rok. W chłodniejszych miesiącach, gdy brakuje pożywienia, odpowiednia karma dostarcza im energii i zapasów tłuszczu niezbędnych do przetrwania zimy. Karma dla jeży Menu Nature Hedgehogs' Insects Delight to bezzbożowa mieszanka zawierająca w swoim składzie owady (60%), skorupiaki i mięczaki. Produkt uzupełnia kategorię pokarmów dla dzikich zwierząt. Zadbajmy o naszych kolczastych sąsiadów – oni z wdzięcznością wrócą do naszych ogrodów!
Dystrybutor: AniDis anidis.pl



Nowa kolekcja M-PETS® Urban Style łączy modny design z trwałością. Smycze, obroże i szelki wykonano z poliestru odpornego na ścieranie (99% z recyklingu butelek PET) i mocnych klamer nylonowych. Łatwe w czyszczeniu, zachowują intensywne kolory przez lata użytkowania.
W ofercie: szelki, smycze, obroże, torba transportowa, plecak, muszki i bandany dla psów i kotów.
Import i dystrybucja: Betta sp. z o.o. / www.betta.pl biuro@betta.pl / 22 763 19 90
Wybarwiający pokarm dla wszystkożernych i mięsożernych ryb akwariowych na bazie trzech owadów: hermetii (15%), jedwabnika (15%) i mącznika młynarka (15%), z formułą Tropical’s Colour Booster. Pokarm dostępny jest w formie płatków oraz granulatu w rozmiarze S i XXS.
• Ryby zyskują intensywne wybarwienie dzięki innowacyjnej formule Tropical’s Colour Booster, opartej na naturalnych karotenoidach.
• Pokarm skutecznie wspiera różnorodne potrzeby ryb, dzięki wysokiej koncentracji karotenoidów o różnej biodostępności i aktywności biologicznej.
• Ryby lepiej rosną i są w doskonałej kondycji dzięki wysokostrawnemu białku owadziemu, bogatemu w kluczowe aminokwasy.

• Lepsze trawienie i silniejszy układ odpornościowy zapewnia obecność białka owadziego, które stymuluje rozwój bakterii kwasu mlekowego o działaniu probiotycznym.
• Naturalna dieta i troska o planetę – wykorzystanie owadów w składzie nawiązuje do naturalnego pokarmu ryb i jednocześnie zmniejsza zużycie wody, energii oraz redukuje ślad węglowy.
• Bezpieczeństwo i czysty skład – pokarm nie zawiera sztucznych barwników ani konserwantów.
• Świadomy wybór dla środowiska – opakowanie w całości nadaje się do recyklingu: puszka, nakrętka i etykieta są w 100% recyklingowalne.
Producent: Tropical www.tropical.pl

Wieloskładnikowy pokarm z dodatkiem larw hermetii (BSF) dla młodych osobników wszystkożernych i mięsożernych żółwi wodnych i wodno-lądowych. Wygodna forma małych pływających pałeczek pozwala w pełni kontrolować ilość zjadanego pokarmu.
• Zawiera larwy Hermetia illucens (BSF) , które charakteryzują się korzystnym stosunkiem wapnia do fosforu oraz wysoką przyswajalnością składników mineralnych.
• Skorupiaki wzbogacają karmę o wartościowe białko, chitynę oraz nienasycone kwasy tłuszczowe (omega-3 i omega-6).
• Wysoka hydrostabilność pałeczek zapobiega wymywaniu składników pokarmowych do wody oraz zapewnia czystą wodę.
• Składniki użyte w recepturze karmy odpowiadają naturalnej diecie żółwi wodno-lądowych i wodnych.
• Karma zapewnia zdrowy rozwój i wzrost żółwi, a także zdrową skorupę i kości.
• Wyjątkowy smak zachęca zwierzęta do żerowania.
• Puszka, nakrętka i etykieta są w pełni recyklingowalne.
Producent: Tropical www.tropical.pl
To zdrowe przekąski w formie kolb dla gryzoni i królików. Suszone, a nie pieczone, dzięki czemu zachowują właściwości odżywcze. Nie zawierają cukru, barwników i konserwantów. Sznurek z naturalnego włókna konopnego jest bezpieczny dla zwierząt w razie zjedzenia. Przekąski są dostępne w trzech wariantach i uwzględniają wymagania pokarmowe różnych grup zwierząt.
• Herbal – bezzbożowa przekąska z nagietkiem, ślazem, rumiankiem i innymi ziołami. Stanowi źródło cennego włókna pokarmowego i bioaktywnych składników roślin. Idealna dla roślinożernych gryzoni i królików.
• Veggie – bezzbożowa przekąska z marchewką, burakiem, pomidorem i ziołami, bogata we włókno pokarmowe, witaminy i minerały. Odpowiednia dla roślinożernych gryzoni i królików.
• Insect – przekąska wzbogacona larwami mącznika młynarka, orzechami, kokosem oraz wyselekcjonowanymi ziołami i nasionami. Stanowi doskonałe źródło wysokiej jakości białka zwierzęcego, naturalnych witamin i minerałów. Idealna dla wszystkożernych gryzoni. www.tropifit.pl



Skontaktuj się i dodaj produkt do swojej oferty: dzial.handlowy@tropical.pl


Cleopatra VII z kangurem – sekret Aborygenów
Prosto z serca australijskich równin – od 77 Seven Seven – na królewski stół Twoich kocich arystokratów. Wyjątkowe mięso kangura – lekkie, naturalne i bogate w składniki odżywcze od wieków było sekretem siły i długowieczności Aborygenów. Dziś ten dar natury został zamknięty w królewskim daniu razem z papają i uwielbianą przez koty kocimiętką.
• ~96% fileta z kangura z papają, olejem z pestek dyni i kocimiętką.
• Witaminy B 6 i B12 – wspierają odporność i metabolizm.
• Żelazo – wzmacnia witalność i transport tlenu.
• CLA – działa przeciwzapalnie.
Gotowany powoli, bez chemicznych dodatków, zachowuje pełnię smaku i wartości odżywczych, prawdziwy rarytas dla najbardziej wybrednych kotów. Cleopatra VII to egzotyczny smak, o którym mówiono już tysiące lat temu – niech teraz podbije królewskie podniebienie Twojego kota.
Zamów teraz i poczuj różnicę w każdym kęsie!
https://www.77seven-seven.pl/product-page/cleopatra-vii-z-kangurempuszka-185g
Nowa kategoria karmy dla psów w technologii Marshmallow – smakuje jak mokra i działa jak sucha. James I to połączenie tradycyjnej karmy suchej z wilgotną konsystencją karm mokrych.
Soczyste – Delikatne – Puszyste – Pianki z mięsa perliczki Mięso z perliczki charakteryzuje się bardzo niską zawartością tłuszczu oraz wysoką zawartością pełnowartościowego białka, które wspiera budowę mięśni i regenerację organizmu. Składniki poddawane są procesowi powolnego gotowania, dzięki czemu karma zachowuje cenne wartości odżywcze i witaminy.
• Chude i dietetyczne mięso z dzikiego ptactwa afrykańskiej sawanny.
• Wspomaga nawodnienie organizmu.
• Hipoalergiczna.
• Bez dodatku cukru i zbóż.
• Wspomaga układ krwionośny.
• Konsystencja ułatwiająca żucie.
• Przyjazna dla dziąseł.
• Łatwa w podawaniu i przechowywaniu. Wskazana dla psów: wybrednych, szczeniąt, dorosłych małej i średniej rasy, wrażliwych stomatologicznie i seniorów. https://www.77seven-seven.pl/product-page/james-i-z-perliczką

Anna Boleyn – przepiórka ze złotem
Anna Boleyn od 77 Seven Seven – karma, w której renesansowa finezja spotyka zmysłową elegancję. Inspirowana postacią kobiety, która odważyła się marzyć, kochać i walczyć o własne miejsce w historii, stworzona dla kotów świadomych swej wartości.
To kunsztowna kompozycja wykwintnej przepiórki – dawnego rarytasu królewskich stołów – jej delikatna, sprężysta struktura i bogaty smak tworzą prawdziwe arcydzieło natury. Morela wnosi szczyptę słodyczy, a nuta złota i oleju szafranowego dodaje złocistego wyrafinowania i harmonii – symbolu piękna i dostojności dworu Tudorów.
Anne Boleyn:
• 95,5% przepiórka (100% filet) – lekkostrawna i naturalnie hipoalergiczna.
• 2% morela – słodycz i bogactwo witamin.
• 2,5% nano złoto, olej szafranowy i witaminy – źródło piękna, wdzięku i gładkiej sierści.
Dla kotów, które – jak Anne Boleyn – mają w sobie pasję i odwagę, by błyszczeć po swojemu.
https://www.77seven-seven.pl/product-page/anne-boleyn-z-przepiórkąpuszka-185g



Poznaj suchą karmę dla psa Saint Martin z gęsiną
od 77 Seven Seven Inspirowaną tradycją, smakiem i zdrowiem. Nie bez powodu w listopadzie wypada dzień Świętego Marcina, a polskie stoły od wieków zdobi gęsina. To nie tylko symbol dostatku i gościnności, lecz także źródło wyjątkowej siły natury.
Według tzw. kalendarza gęsiego właśnie w listopadzie rozpoczyna się Nowy Rok Gęsi – moment, gdy kończy się ich cykl miłosny, a mięso osiąga najwyższą jakość i wartości odżywcze. Nic dziwnego, że na królewskich dworach świętowano wtedy ucztami pełnymi dań z gęsiny.
Zgodnie z tą tradycją powstała sucha karma Saint Martin z gęsiną, pełną naturalnych składników:
• witamin A, E, PP, z grupy B,
• cennych minerałów: żelaza, cynku, potasu i magnezu,
• kwasów omega-3 i omega-6.
Wspierających serce i odporność szczególnie w chłodne, jesienne dni. Saint Martin – karma stworzona z sercem i dla serca. https://www.77seven-seven.pl/product-page/martin-z-gęsiną
Dorsz + Cynamon to wyjątkowa uczta inspirowana smakiem epoki Filipa V, króla Francji znanego z umiłowania porządku, umiaru i dworskiej elegancji.
Dorsz – jeden z najbardziej cenionych darów morza – podawany w dni postne symbolizował czystość, dostatek i mądre wybory. W duchu tej tradycji powstał nasz przysmak:
• delikatne, chrupiące kąski,
• 95% dorsza – lekki, bogaty w białko i nienasycone kwasy tłuszczowe,
• z nutą tymianku – wspierającego trawienie,
• rozmarynu – chroniącego komórki,
• cynamonu – wspierającego odporność,
• suszony ciepłym powietrzem,
• zachowuje naturalne wartości odżywcze i głęboki morski aromat,
• bez konserwantów i sztucznych dodatków,
• idealny dla psa o królewskim apetycie.

https://www.77seven-seven.pl/product-page/philip-v-mini-crispy-bites-z-dorsza-z-ziołami
Zimowo-świąteczna limitowana kolekcja od WOW, DOG'S LOVE & CAT'S LOVE
Limitowane świąteczne produkty ponownie podbiją serca psów i kotów: te specjalne edycje zachwycają wysokiej jakości, sezonowymi składnikami oraz uroczym zimowo-świątecznym designem.
• WOW DOG zaoferuje w tym roku wyjątkową nowość: przysmaki dentystyczne w kształcie płatka śniegu, z jabłkiem i cynamonem, które nadadzą każdemu kęsowi odrobinę zimowej magii! W ofercie WOW DOG także kalendarz adwentowy z przysmakami w postaci kosteczek ze 100% mięsa.

• WOW CAT przygotował kalendarz adwentowy, w którym czeka pyszny wybór przekąsek: chrupiące przekąski z łososiem i kurczakiem oraz kremowe przekąski z łososiem, wołowiną i kurczakiem.
• Na koty czeka także kalendarz adwentowy CAT'S LOVE z liofilizowanymi przekąskami z filetu kurczaka, wołowiny i krewetek grenlandzkich.
• DOG'S LOVE przygotował zimowe trio: ekologiczny kalendarz adwentowy, ekologiczne zimowe chipsy mięsne i karma mokra z delikatnego mięsa kaczki z jabłkami i żurawiną.
Producent: PetCo GmbH Austria
Dystrybutor: Best 4 Animal Care Sp. z o.o., www.b4ac.pl, kontakt@b4ac.pl, tel. 782 633 779

Zaskocz swoich klientów szeroką ofertą ze świątecznej kolekcji Renske. W ramach limitowanej edycji dostępne są karmy mokre, przysmaki i gryzaki:
• Christmas Dinner, czyli karmy mokre do wyboru w 2 smakach: gulasz z kaczki i dziczyzny z morelami oraz indyk z żurawinami. Przygotowane ze świeżego mięsa delikatnie gotowanego na parze. Wykwintności daniom dodają warzywa i owoce oraz zioła, jak rozmaryn i pietruszka.
• Pyszne i chrupiące ciasteczka w 2 wersjach: ze świeżych ryb (80% łososia, białej ryby i pstrąga) oraz z jagnięciną i dodatkiem siemienia lnianego na piękną sierść oraz glukozaminą i chondroityną dla mocnych stawów i mięśni.
• Gryzaki z sera himalajskiego także w 2 wersjach, z truskawką i dodatkami redukującymi stres i wspierającymi stan relaksu, jak L-tryptofan i melisa. Idealny gryzak na zabiegane święta, dom pełen gości i atrakcyjny prezent dla psa pod choinką. Druga wersja gryzaka wzbogacona spiruliną, kwasami tłuszczowymi omega-3, glukanami drożdżowymi i cynkiem wspiera zdrową skórę, lśniącą sierść i silną odporność. Idealny gryzak na okres zimowy. Obie wersje dostępne są w rozmiarze M.
Producent: Renske Natural Petfood
Dystrybutor: Best 4 Animal Care Sp. z o.o., www.b4ac.pl, kontakt@b4ac.pl, tel. 782 633 779
Renske przygotowało pyszne niespodzianki na święta Bożego Narodzenia także dla kotów: limitowaną edycję karmy i przysmaków. Mokra karma kurczak z królikiem o konsystencji delikatnego pasztetu i wysokiej zawartości mięsa skradnie kocie podniebienia. Przysmaki w kształcie małych, lekko miękkich serduszek zawierają 95% najwyższej jakości królika, są wyjątkowo smaczne i wyróżniają się niską zawartością tłuszczu . Idealne pomysły na prezent dla wszystkich kocich przyjaciół.
Producent: Renske Natural Petfood

Dystrybutor: Best 4 Animal Care Sp. z o.o., www.b4ac.pl, kontakt@b4ac.pl, tel. 782 633 779

Prowadzisz sklep zoologiczny, jesteś polskim producentem lub dystrybutorem? Dołącz do programu Polskie Punkty i już dziś nagradzaj swoich klientów – zarówno B2B, jak i B2C!
Poziomo
1) miejsce słynnej bitwy Spartan i Persów
3) jednoczesny ruch króla i wieży w szachach
5) mieszkanka Paryża
10) zabierasz ją w podróż
11) linia brzegowa
12) możesz się po niej wspinać
14) największy współcześnie żyjący gryzoń
17) kilkuramienny świecznik
20) obrzydliwość inaczej
22) popularny obecnie napój
23) kontrowersyjny element wyposażenia klatki gryzoni
25) łoże tortur
26) naturalna skała osadowa o silnych właściwościach adsorpcyjnych
27) przeciwieństwo amatora
28) zbieranie grzybów
Pionowo
2) na zupę lub do ketchupu
4) symbol związany z egipskim bogiem Ra
5) słynny czeski przeszkodowy wyścig konny
6) jedna z możliwości
7) w niej gluten
8) podlegają jej środki trwałe
9) tego warzywa nie lubią dzieci
13) mała rana
15) potocznie nauczyciel
16) nie paski
18) śledztwo
19) do układania
21) nastawienie tylko na zysk
23) wędlina z krwią
24) blask księżyca
Fundatorem nagród jest:

Życzymy miłej zabawy!
Na trzy osoby, które jako pierwsze prawidłowo rozwiążą krzyżówkę i prześlą jej zdjęcie na adres redakcja@zoobranza.com.pl , czekają nagrody niespodzianki ufundowane przez wydawnictwo CHCĘ, ROBIĘ, MAM !

Laureatami poprzedniej edycji naszej krzyżówki zostali Państwo: Krzysztof Walczak, Aleksandra Drozd, Agnieszka Gałecka. Zwycięzcy otrzymali nagrody-niespodzianki ufundowane przez wydawnictwo CHCĘ, ROBIĘ, MAM !
Wydawnictwo: FIDELIS PRESS Sp. z o.o. Redaktor naczelna i prowadząca: dr n. wet. Joanna Zarzyńska joanna.zarzynska@zoobranza.com.pl
Reklama: Bernadeta Stańko-Łuczka bernadeta.stanko@zoobranza.com.pl tel. 606-448-000
Adres redakcji: ZooBranża ul. Warszawska 11B lok. 13 05-090 Dawidy Bankowe
Copyright © FIDELIS PRESS Sp. z o.o.
ISSN 2450-0372
Nakład: 4000 egz.
Współpraca autorska: prof. dr hab. Michał Jank dr n. wet. Grzegorz Madajczak prof. dr hab. Piotr Ostaszewski dr inż. Jacek Wilczak dr n. wet. Joanna Zarzyńska Adrianna Iwan, Natalia Młodnicka, dr inż. Rafał Maciaszek, Gniewomir Kuciapski, mgr Berenika Niesłuchowska-Kasprzycka, dr Agnieszka Kurosad, Laura Zarzyńska i inni.
Projekt graficzny: PRO CREO Piotr Łuczka piotr.luczka@procreo.pl
Skład i łamanie: Łukasz Wójcik
Korekta: Ewa Wilczyńska
Redakcja nie zwraca materiałów nie zamówionych. W przypadku materiałów opublikowanych redakcja zastrzega sobie prawo do ich skracania i zmiany tytułów. Warunkiem przyjęcia materiału do druku jest złożenie przez autora oświadczenia, że nie został on złożony do opublikowania w innej redakcji.
Materiały publikowane w magazynie ZooBranża mogą by wykorzystywane publicznie pod warunkiem podania źródła.
Opinie wyrażane na łamach pisma nie zawsze są zgodne z poglądami redakcji.
Wydawca nie ponosi odpowiedzialności za treść opublikowanych ogłoszeń i reklam. Jednocześnie zastrzega sobie prawo odmowy przyjęcia lub odmowy publikacji albo też wstrzymania publikacji ogłoszenia, reklamy lub insertu na wcześniej uzgodnionych warunkach, bez ponoszenia jakiejkolwiek odpowiedzialności z tego tytułu, z przyczyn siły wyższej, sprzeczności ogłoszenia, reklamy lub insertu z prawem bądź zasadami współżycia społecznego (dobrymi obyczajami), albo też sprzeczności z linią programową bądź charakterem publikacji, a także z negatywną oceną przez redakcję tytułu treści zawartych w ogłoszeniu, reklamie lub insercie, oraz sądowego zabezpieczenia bądź zgłoszenia przez osoby trzecie przeciwko Wydawcy, lub osobom trzecim roszczeń lub uprawdopodobnionych zastrzeżeń związanych z ogłoszeniem, reklamą lub insertem bądź ich emisją w zakresie objętym umową.







